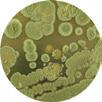

HEAT & FANS
BROAN





Broan-NuTone®canimproveindoorairqualityineveryroom of the home. From clearing humidity in the bathroom to removing steam and other airborne effluents in the kitchen, no company knows residential and light commercial ventilation like Broan-NuTone. After countless innovations and a commitment to indoor air quality, trust Broan-NuTone toclearupeveryconcern.




When your home breathes, you breathe easier, too.


removes excess moisture and odor from any room in the home, and can also provide continuous, whole-house ventilation.

expels cooking effluents from food preparation to eliminate airborne pollutants from spreading through the entire house.

efficiently exchange inside air with fresh outside air, and remove airborne particulates with HEPA filtration.

is a fully automated fresh air solution that monitors and manages indoor air quality to eliminate pollutants and bring in fresh, clean air from the outside. See page 9 to learn more.
Broan-NuTone® can improve indoor air quality in every room of the home. From clearing humidity in the bathroom to removing steam and other airborne effluents in the kitchen, no company knows residential and light commercial ventilation like Broan-NuTone. After countless innovations and a commitment to indoor air quality, trust Broan-NuTone to clear up every concern.
Not all homeowners recognize what contributes to poor indoor air quality, the potential effects and harm, and how to address these problems. Broan-NuTone® is here to help. For 90 years, Broan-NuTone has led the industry with residential ventilation solutions that improve indoor air quality and provide healthier home environments.

Moisture that is not properly ventilated can cause mildew and mold formation, potentially leading to structural and health problems.
Exhaust ventilation solutions from Broan-NuTone remove humidity at the source to help maintain the optimal humidity balance of 40–60%.

Off-gassing from construction materials, carpeting, adhesives and synthetic materials—as well as solvents from common household cleaners—can accumulate in tightly built homes. Look to Broan-NuTone for continuous ventilation solutions that meet ASHRAE 62.2.

Particulates
from dust, allergens, pet dander, and more can contribute to poor indoor air quality up to 100 times more polluted than outside air.
A properly ventilated home creates a more enjoyable, comfortable and healthier environment.

Cooking byproducts can infiltrate the whole house in minutes. Grease, oils and aromas settle permanently into carpets, furniture, clothing and other surfaces. Kitchen ventilation solutions help eliminate cooking effluents for a cleaner, more comfortable and healthier environment.
America’s most used and trusted residential ventilation company. Broan-NuTone® is proud to have our American-made ventilation and home comfort and convenience products installed in 90 million homes across the country.



It’s earned

Nine decades ago, an engineer in Southeastern Wisconsin named Henry Broan had a revelation: wouldn’t a built-in mechanical ventilation solution help to provide better indoor air quality in the kitchen? And so, Motordor ® was conceived—the first kitchen ventilator—and a company was born. The invention of the bath fan soon followed, as the passion for improving indoor air quality continued.
Throughout the years, Broan-NuTone® has led the industry with countless innovations. From the first energy-efficient certified fans and range hoods, to quiet ventilation solutions that are easier than ever to install. It’s because Mr. Broan knew leadership is earned and proven through a passion and commitment to finding novel solutions to real problems time and time again. This is why Broan-NuTone has taken the job of improving air quality in our homes very seriously for 90 years.
The American Society of Heating, Refrigeration and Air Conditioning Engineers set the ventilation standard for low-rise residential buildings with ASHRAE 62.2. It established the minimum standard for spot ventilation of bathrooms at 50 CFM delivered airflow at 3.0 sones or less, and specifies requirements for whole-house ventilation at a max sound rating of 1.0 sone for ventilation fans.
Use these tables to find whole-house solutions that help meet ASHRAE 62.2.
ENERGY STAR® fans use 70% less energy, on average, than standard models and may qualify for local utility rebates
*With 6" duct (0.3 sones with 4" duct)
Saving energy saves tomorrow by protecting our resources. We are honored to have received the ENERGY STAR® Sustained Excellence Award.

With CODE-KEY, select compliant ventilation solutions with confidence.
• Choose state, home size facts and user preferences
• Get recommended ventilation products instantly
• Change parameters to see a range of options
• Open a browser on any device and go—it’s easy

Flex Series™ is about time-saving, flexible solutions for new construction or roomside retrofit. Innovative features simplify roomside installation and improve building airtightness like never before. With fresh cover designs and a full range of fans, fan/lights and sensing models, there’s a Flex Series™ solution for every installation.





FoldAway ® mounting ears simplify new construction and fold flat for roomside retrofits.

TrueSeal® damper technology reduces air leakage up to 50%, and saves up to 1 HERS point and $9 per year in operating costs.*
EzDuct™ connector enables roomside installation without attic access. Pull the 4" duct through, attach the EzDuct™ connector and set it with one screw.
LED lighting offers energy efficiency and longevity. The 11-watt, 800 lumen integrated module lasts up to 25,000 hours.
Flex DC Series.™ We took Flex even further. Flex DC Series ventilation fans provide three CFM settings accessible at the touch of a switch. You have the best solution for any installation. An energy-efficient DC motor makes it possible, all while running at less than 1.0 sone at all fan speeds.


Available on select models
Features


Scan or tap the code to see how Flex Series™ fans simplify installation.
• 50% more airtight
• Select 50, 80 or 110 CFM with a switch
• Dimmable LED fan/lights
• Humidity sensing models
• Quiet operation as low as <0.3 sones
• Flange kit for a leak-free seal (sold separately)
• Enhanced energy efficiency—up to 14.7 CFM/watt
Hanger Bars | Humidity Sensing | LED Lighting
The Flex DC Series™ was built to give you what matters most. With a selectable DC motor, you can switch between 50, 80 or 110 CFM to meet any room ventilation requirement as well as ASHRAE 62.2 for spot and dwelling unit ventilation. The brushless DC motor lasts longer than standard motors and achieves 90% efficiency, saving money long after installation.
• Selectable DC motor enables right-sized ventilation for any room
• Quiet operation at less than 1.0 sone at all CFM speeds
• TrueSeal® damper technology creates an airtight seal from inside the housing
• 4" round duct connector compatible with any Broan duct increaser

• UL Listed for use over tub and shower when connected to a GFCI protected branch circuit
• Type IC, fits 2" x 6" and larger construction


AE50110DC

Installation and retrofit upgrades just got easier. Go flangeless or add the flange by simply snapping it on the side of the fan housing for a professional finish and tighter, leak-free seal. UP

AE50110DCS
• Sensaire™ Sense on Rise technology

AE50110DCSL, AE50110DCL
• Dimmable, Title 24 compliant LED lighting
• Sensaire™ Sense on Rise technology on model AE50110DCSL
• Grille pictured is AE50110DCSL
• Detects a rapid rise in humidity
• User adjustable sensitivity control
• Easy-to-set shut-off timer: 5–60 minutes
• UL Listed for use over tub and shower when connected to a GFCI protected branch circuit

AE80S, AE110S
• FoldAway® mounting ears enable easy roomside installation
• Fits in 2x6 ceiling construction
• ENERGY STAR® certified
• HVI Certified

AE80SL, AE110SL
• FoldAway® mounting ears enable easy roomside installation
• Bright, energy efficient LED Lighting
• Fits in 2x6 ceiling construction
• RD2 radiation damper accessory for Flex Series (see page 61) Broan Model CFM Sones
Today’s tightly built homes are models of energy efficiency. But sometimes, what you can’t see requires the most attention. The Overture™ system monitors, measures and manages indoor air quality at the room level. When high levels of humidity, TVOCs, CO2 and temperature are detected, Overture™ automatically starts ventilation devices to exhaust bad air and introduce fresh air.






Contractors recognize the Broan-NuTone® ventilation brand above all others.



See how SurfaceShield™ kills bacteria and viruses at the touch of a switch.
Scan or tap the code to learn more.
• FoldAway® mounting ears enable easy new construction and roomside replacement installations
• TrueSeal® damper technology forms a tight seal to reduce backdrafts
• EzDuct™ connector creates an air-tight seal inside the housing and enables roomside installation without attic access
• Effective ventilation clears humidity and odors
• UL Listed for use over tub and shower when connected to a GFCI protected branch circuit
• All models starting with AE are ENERGY STAR® certified

• Fan/Light with Incandescent E26 Base (bulb not included)


Convert your ventilation fan to a SurfaceShield™ bacteria- and virusfighting solution. The VVLED upgrade light is compatible with the following models: AE50110DCL, AE50110DCSL, AE80BL, AE80SL, AE110L, AEN80BL, AEN110L, AE80LK and AE110LK. See page 21 to learn more.
• CleanCover design stays cleaner longer
• LED Fan/Light with 11 watt, 800 Lumens, 3500K integrated module
• 25,000-hour LED for maintenance-free convenience

• LED Fan/Light with 11 watt, 800 Lumens, 3000K, 80 CRI integrated module
• 25,000-hour LED for maintenance-free convenience

• CleanCover design stays cleaner longer
• Features integrated dimmable LED with color adjustable CCT lighting, warm (3000K), bright (3500K), cool (4000K) and daylight (5000K)
• 25,000 hour LED for maintenance-free convenience
ENERGY STAR® fans use 70% less energy, on average, than standard models and may qualify for local utility rebates
*Bulb not included
• FoldAway® mounting ears enable easy new construction and roomside replacement installations
• TrueSeal® damper technology forms a tight seal to reduce backdrafts
• EzDuct™ connector creates an air-tight seal inside the housing and enables roomside installation without attic access
• Effective ventilation clears humidity and odors
• UL Listed for use over tub and shower when connected to a GFCI protected branch circuit
• All models starting with AE are ENERGY STAR® certified

STAR® fans use 70% less energy, on average, than standard models and may qualify for local utility rebates 9-1/4" 10"


We believe that Veterans, particularly those who returned wounded, deserve a better life. So we're proud to support the Homes For Our Troops foundation by donating products to help Veterans breathe fresh, clean air at home.
Broan-NuTone.com


The very quiet Broan-NuTone QT® Series is the ideal solution for any room that benefits from ventilation. Most QT® models operate at less than one sone—the sound of a quiet running refrigerator. But quiet operation doesn’t mean less power. Installed properly, the QT® Series maintains full-rated airflow in real-world installations.

• Selectable DC motor enables right-sized ventilation for any room
• 30% tighter housing than competitive models*
• Flangeless housing facilitates a seamless installation
• Quiet operation at less than or equal to 0.7 sones at all CFM speeds
• TrueSeal® damper technology creates an airtight seal from inside the housing
• 6" round duct connector to reduce static pressure in ducting
• UL Listed for use over tub and shower when connected to a GFCI protected branch circuit
• Type IC, fits 2" x 8" and larger construction

QTXE110150DC
• Detects a rapid rise in humidity
• User adjustable sensitivity control
• Easy-to-set shut-off timer: 5–60 minutes

• Fan cover-mounted humidity sensor for fast reaction time
• Sensaire™ Sense on Rise technology
• RDFU1 radiation damper available while supplies last with RDJUMPQ accessory
• Hanger bar system up to 24" for flexible installation in all types of construction

QTXE110150DCL
• Bright, energy-efficient LED lighting
• UL Listed for use over tub and shower when connected to a GFCI protected branch circuit
• ENERGY STAR® certified
• HVI Certified

QTXE110150DCSL
• Bright, energy-efficient LED lighting
• Fan cover-mounted humidity sensor for fast reaction time
• Sensaire™ Sense on Rise technology
• RDFU1 radiation damper available while supplies last with RDJUMPQ accessory
• Hanger bar system up to 24" for flexible installation in all types of construction
*Compared to competitive fans; based on software calculations and analysis conducted by Broan.
Testing reflects total fan housing air tightness.

Simplify Installation with Project Packs. Project packs are ideal for contractors and builders who have yet to pick out the final product. With the housing for the fan sold separately from the cover and motor, contractors are able to continue with construction and not have to worry about damaging, losing or storing the product. Once all construction is complete, the purchase of a finish pack, 4 covers and 4 motor/blower wheels, can be made to add the finishing touches to the room.

Premium Radiation Damper.
When the air temperature passing through the damper exceeds 165°F the fusible link melts, triggering the thermal fabric to automatically close across the damper. Airflow is interrupted by a flame and heat barrier, preventing the rapid spread of fire to other areas. Scan or tap the code to learn more.

• Very quiet operation 0.3 to 1.4 sones
• 80 CFM to 150 CFM
• 6" ducting for superior performance
• Hanger bar system up to 24" for flexible installation in all types of construction
• Motor engineered for continuous operation

QTXE110S
• Fan cover-mounted humidity sensor for fast reaction time
• Sensaire™ Sense on Rise technology
• Hanger bar system up to 24" for flexible installation in all types of construction
• UL Listed for use over tub and shower when connected to a GFCI protected branch circuit
• Fits 2x8 ceiling construction
• ENERGY STAR® certified
• HVI Certified
• Radiation damper RDFQF available separately

QTXE080, QTXE110, QTXE150





We didn’t just change one thing to make installation faster. We changed everything.
ULTRA Green® . The perfect solution to meet today’s continuous ventilation requirements. Built for easy installation in either new construction or retrofit applications, the ULTRA Green® Series makes it simple to ventilate any room in the house. Exclusive ULTRA Smart™ DC Motor and Control Technology enables fans to maintain their powerful operation—even at high static pressures—and provide required air movement levels for whole-house ventilation, all while meeting spot ventilation needs on-demand. Continuous CFM levels can be precisely adjusted to meet the specific needs of each home.




For the fastest, easiest, most universal solution for any installation, think ULTRA® Series. With a unique telescoping mounting frame that installs roomside on retro-fits and an easy-to-insert housing and blower that snap into place, you’ll never have another difficult installation—no matter what’s behind the drywall.

• HVI Certified at <0.3 sones, ULTRA Silent™ sound technology provides the quietest sound rating obtainable
• 80 or 110 CFM
• Intermittent and continuous ventilation
• ULTRA Smart™ DC Motor and Control Technology monitors CFM output and adjusts motor speed to ensure rated air movement ULTRAQuick® installation technology enables fast, easy, universal installation

• XB and ZB models feature 6" ducting 80 CFM models include an optional 6" to 4" duct reducer
• UL Listed for use over tub and shower when connected to a GFCI protected branch circuit
• Type IC
• Fits 2x8 ceiling construction
• Optional RDFU premium radiation damper kit available



ENERGY STAR® fans use 70% less energy, on average, than standard models and may qualify for local utility rebates
*With 6" duct (with 4" duct 0.3)




Scan the code to see how ULTRA® Series fans simplify installation.


HVI Certified at <0.3 sones, ULTRA Silent™ sound technology provides the quietest sound rating obtainable
50, 80 or 110 CFM
Intermittent and continuous ventilation
• ULTRA Smart™ DC Motor and Control technology monitors CFM output and adjusts motor speed to ensure rated air movement ULTRAQuick® installation technology enables fast, easy, universal installation

XB50L1, XB80L1, XB110L1, ZB80L1, ZB110L1
• Bright, energy-efficient LED lighting
• XB and ZB models feature 6" ducting—50 and 80 CFM models include an optional 6" to 4" duct reducer
• UL Listed for use over tub and shower when connected to a GFCI protected branch circuit
• Type IC
• Fits 2x8 ceiling construction
• Optional RDFU Premium Radiation Damper Kit available

XB50, XB80, XB110, ZB80, ZB110
STAR® fans use 70% less energy, on average, than standard models and may qualify for local utility rebates
*With 6" duct (with 4" duct 0.3)

With CODE-KEY, select compliant ventilation solutions with confidence.
• Choose state, home size facts and user preferences
• Get recommended ventilation products instantly
• Change parameters to see a range of options
• Open a browser on any device and go—it’s easy

General Features & Benefits
• Extremely quiet operation with innovative sound reduction technologies
• QStream™ technology features airflow-smoothing baffles to reduce turbulence
• Optional RDFU Premium Radiation Damper Kit available for RB models

RB80L1, RB110L1

Broan Model CFM Sones Light Duct ENERGY STAR® Overture® Compatible Cover Size RB80L1
ENERGY STAR® fans use 70% less energy, on average, than standard models and may qualify for local utility rebates
ULTRA® Ventilation Fans are engineered to be the fastest, easiest, most universal installation in remodel, retrofit or new construction—in any type of joist or truss system. Exclusive features simplify installation to save valuable time and money.





Inside/outside wiring capability provides flexible new or retrofit installation
Pre-installed screws in the mounting frame enable quick installation
Vertical positioning tabs ensure the housing is in the right place
The expandable mounting frame adjusts from 14"–24" and fits any type of joist, I-Joist or truss construction



You wipe
every surface. Now shield them all day long.
SurfaceShield™ with Vyv™ antimicrobial light technology is helping keep your spaces cleaner. SurfaceShield quietly removes excess humidity while killing* viruses and fighting bacteria, mold, and fungi growth in your bathroom or other humidity prone environments. With the flip of a switch you’ll spend less time cleaning and more time with the ones you love.
Shower curtains, shower walls, toilet seats, door handles, faucets and sinks are all places viruses, odor and illness causing bacteria, mold, and mildew accumulate. By preventing microbes from lingering, BroanNuTone’s SurfaceShield™ technology works doubly hard by removing airborne pollutants from the room and reducing microbial buildup.
That technology is coupled with the powerful and quiet 110 CFM Roomside™ series bathroom ventilation fan to remove humidity and pollutants from the air in the room.
*Testing on a non-enveloped virus (MS2 bacteriophage) showed a 99.985% reduction in controlled laboratory testing in 6 hours on hard surfaces. MRSA and E. coli showed 90%+ reduction in controlled laboratory testing in 24 hours on hard surfaces. Results may vary depending on the amount of light that is reaching the surfaces in the space where the product is installed and the length of time of exposure. Use of Vyv antimicrobial light is not intended to replace manual cleaning. Get more info at vyv.tech/virus

SurfaceShield™ Anti-bacterial Fan/Light AR110LKVV, ARN110LKVV
• EzDuct™ connector enables easy roomside installation
• TrueSeal® damper technology reduces air leakage up to 50%
• SnapFit Flange Kit offers flexible installation for new construction or retrofit upgrades
• Foldable mounting ears allow for easy installation in both new construction and room-side replacement applications
• Powerful enough for rooms up to 105 sq. ft.
• Brighter white covers blend in to match most common ceiling paint
• Corrosion resistant galvanized steel housing stands up to moisture
• Permanently lubricated AC motor engineered for continuous operation
Turn your existing fan/ light into a SurfaceShield™ anti-bacterial solution and virus-killing solution. With an upgrade kit or LED module, many Broan-NuTone® fan/lights can be converted into a SurfaceShield™ solution in a matter of minutes. Both are compatible with certain legacy Broan® or NuTone InVent ®, Flex Series™ , or Roomside Series fan/light.

Upgrade Fan Cover FG1000VV
• CleanCover® stays cleaner longer with less louvers to trap dust and dirt
• Two lighting modes: an everyday LED white light perfect for task lighting and the SurfaceShield™ continuous antibacterial mode
• Compatible with existing ventilation fan housing dimensions of 91⁄4" x 10" (lighted fans only) Broan
• No drywall or additional wiring work required. Plugs directly into existing lighting connection

• Replace the LED lighting module in your existing fan/light
• Two lighting modes: an everyday LED white light perfect for task lighting and the SurfaceShield™ continuous antibacterial mode





Experience greater ambience in your home. The ChromaComfort ® fan combines colorful LED lighting options, superior ventilation, and quiet operation to create a colorful experience for any room of your house. Control light settings, brightness, timers, and fan speed all at the touch of a button.
Choose from 24 different hues to fit your aesthetic mood.
The uniquely-designed, multi-color LED chroma light features dimmable LEDs so you can create any color ambience and adjust brightness levels.

SPK110RGBL, SPKN110RGBL
• Enjoy crisp, bold sound with a built-in Sensonic™ Stereo Bluetooth® speaker
• Create your own personal experience with 24 selectable colors via the included wall control or over 16 million choices on the free smartphone app
• Brilliant lighting controlled with included wireless wall control or app

• Continuous color transitions
• Bluetooth® wireless technology for app connection
• Room-side installation means no attic access required


Use the included multi-function wall control or download the free ChromaComfort™ app and connect to Bluetooth® wireless technology to easily adjust light settings, set timers, control the fan, and customize colors.



Ventilation for the music fan.
Unlike wireless speakers that require counter space, Sensonic ® speakers with Bluetooth® wireless technology fill your room with rich sound from above. From hard rock to news talk, play any audio through the dual high-fidelity speakers and enjoy entertainment and privacy at the touch of a button.




SPK110
• Dual high-fidelity Sensonic® speakers
• Brilliant audio performance concealed behind your fan cover
• Play any audio through most Bluetooth® enabled devices
• Effective, extremely quiet ventilation clears humidity and odors quickly
• UL Listed for use over tub and shower when connected to a GFCI protected branch circuit
• Type IC for use in direct contact with thermal insulation
• Fits 2x8 ceiling construction
• Includes unique spacer for easy I-joist mounting
• ENERGY STAR® certified

SPK80L
• High-fidelity Sensonic® speaker
• 80 CFM
• 2.5 sones
• Bright, energy-efficient LED light
• Most common bath fan size—easy DIY project
• Tapered, polymeric 4 in. round duct fitting for easy, positive duct connection and no metallic clatter
• UL Listed for use over a bathtub or shower when connected to a GFCIprotected branch circuit to provide more direct ventilation (ceiling mount only)
• Bright white covers match most common ceiling paint
• Corrosion-resistant galvanized steel housing stands up to moisture
• Permanently lubricated AC motor engineered for continuous operation
cover)
4-pack)
ENERGY STAR® fans use 70% less energy, on average, than standard models and may qualify for local utility rebates

Upgrade Fan Covers
FG800SPKS | FG800SPKNS**
In just minutes, upgrade your classic or legacy bath fan models with Bluetooth® wireless speaker capability and bright, energyefficient LED lighting.
Visit Broan-NuTone.com for the list of compatible models.
**While supplies last


Scan or tap the code to see installation. No drywall work or extra wiring required. See page 45 for more information.
Imagine a fan/light combination fixture that unobtrusively blends into the ceiling. Or a statement fan/light with a stunning LED perimeter glow that showcases your unique décor. Our decorative series provides the necessary ventilation, all while meeting your decorating challenges without compromising your style.



• High efficiency centrifugal fan
• 70 CFM or 50–80 CFM, see table below
• Trim matches designs of major recessed light manufacturers
• Put multiple units in larger rooms
• All models UL Listed for use over tub and shower when connected to a GFCI protected branch circuit

• 744LED includes 9.5 watt, GU24 based LED bulb
• 744 and 744NT require PAR30L or PAR30LN type bulbs (not included). Both products use a standard E26 base (R30 or BR30 for standard applications)
• 67⁄8" high housing appropriate for new construction and 2" x 8" ceiling joists
• 4" round duct connector
• Wall control switches available, see pages 48–51
• Type IC, sealed housing
• Not for use over cooking surfaces

744RNL
• Selectable speeds of 50–80 CFM
• Quiet operation of 0.3 and 2.0 sones
• E26 LED bulb included
• Adjustable brackets to make installation easier
• ENERGY STAR® certified
• Choose bronze, nickel or white trim rings



744L
• White trim ring included
• Selectable CFM with speeds of 50 or 80 CFM
• Quiet operation of 0.3 sones and 2.0 sones
• Matches most recessed lights to blend in seamlessly
• Plug-in permanently lubricated motor
• Rugged galvanized steel construction
• Adjustable mounting brackets for ease of installation
• UL listed for use over bathtubs and showers when connected to a GFCI protected branch circuit
• UL listed for use in insulated ceilings (Type IC)


Scan or tap the code to see the 744RNL installation video.

Ventilation can be beautiful, as well as functional.
It might look like an attractive lighting fixture, but a decorative solution from Broan-NuTone brings powerful ventilation into any room—beautifully. Choose from styles and finishes that complement fixtures, finishes and hardware while delivering the ventilation power you need. It really is a breath of fresh air.

• Dimmable integrated LED module (except on 770RLTK/770RNLTK)
• Sturdy, easy, four-point mounting directly to the joist

AER110SLW, AERN110SLW, AER80LWH, AERN80LWH
• Low-profile designer style fan cover
• AER110SLW and AERN110SLW have humidity sensing capabilities to rapidly remove moisture
• AER110SLW and AERN110SLW are UL listed for use in insulated ceilings (Type IC)
• All models except AR80LWH are ENERGY STAR® Certified
• Motor engineered for continuous operation
• Rugged, galvanized steel construction

AER110LBN
• White fan covers complements any décor
• Fits in 2x6 ceiling construction
• 4" duct / E26 base lighting
• Designed to fit the space of a heater/fan/light
• UL listed for use over tub and shower when installed in a GFCI protected circuit

AR80MB
• Matte black decorative luminaire provides a distinctive accent
• Room-side retrofit install with EzDuct™ connector—no attic access required
• TrueSeal™ Damper reduces air leakage up to 50%
• Foldable mounting ears enable easy installation—new construction or retrofit
• AC motor engineered for continuous operation
STAR® fans use 70% less energy, on average, than standard models and may qualify for local utility rebates

• Includes two easy to change trim kits to match any décor, brushed nickel or brushed bronze
• Drywall cut completely covered with included adaptor plate
• Rugged, 26-gage galvanized steel construction
• Sturdy key-holed mounting brackets for quick and accurate installation
• 60 watt maximum, A19 type, E26 bulb or energy efficient equivalent (bulb not included)
• Not to be installed over a bathtub or shower enclosure
• UL listed for use in insulated ceilings (Type IC) Broan

• Low-profile designer style fan cover
• Includes three easy-to-change trim kits to match any décor: white, brushed nickel or brushed bronze
• Dimmable integrated LED module
• Sturdy, easy, four-point mounting directly to the joist
• Motor engineered for continuous operation
• Rugged, galvanized steel construction
• ENERGY STAR® Certified
• UL listed for use in insulated ceilings (Type IC)
STAR® fans use 70% less energy, on average, than standard models and may qualify for local utility rebates





For some installations, conventional ventilation simply won’t fit. Where multi-family applications require it, the LoProfile fan is narrow enough to be installed in a wall between 2x4 studs. If plumbing or electrical obstructions are found behind the drywall in ceiling remodel applications, the fan still fits without having to move anything. That way, any room can have powerful, quiet, efficient ventilation.
• Fits in 2x4 ceiling or wall construction
• >50 CFM at 0.25" static pressure meets ASHRAE 62.2 local ventilation requirements (with 4" oval duct or 3" round duct)
• Efficient operation lowers utility bills
• Ideal for multi-family applications
• Compatible with RDF1 Premium Radiation Damper (LP50100DC compatible with RDF2 Premium Radiation Damper)
• Project packs available
• 80 CFM with 4" duct ensures ample air movement; 70 CFM with 3" duct reducer
• 4" oval or 3" round duct connection for installation flexibility (LP110 and LP50100DC come with 4" duct only)

• Selectable CFM (LP50100DC only)
• May be used in compliance with Title 24
• TrueSeal® damper technology creates an airtight seal from inside the housing
• Maintains constant CFM to higher static pressure over the competition (LP50100DC only)
LP50100DCF Fan Finish Pack
Broan ® LoProfile series housing pack, 50-80-100 Selectable CFM, ENERGY STAR ®

• UL Listed for use over tub or shower when connected to a GFCI protected branch circuit
• May be used with a radiation damper in multi-family homes
• Fits 2x4 wall or ceiling installation
LPDCH Housing Pack
Broan ® LoProfile Series Housing Pack, 50-80-100 Selectable CFM, ENERGY STAR ®



Get instant heat, right when you need it.
Exactly where you want it.
No matter where you live, there’s certainly one room you never want to be chilly—the bathroom. Whether it’s taking a morning shower, or relaxing in a whirlpool at the end of a long day, your family appreciates a warm, comfortable bathroom. Instead of waiting for the whole house to heat, get powerful heating, light and ventilation at the touch of a switch. Our heater fan/lights provide instant heat to quickly warm up the room, quiet ventilation to remove excess humidity, and convenient light. Operate each feature separately or simultaneously—no furnace required.
General Features & Benefitss
• Dimmable LED lighting with adjustable color temperature on FLED models
• Bright white fan cover matches any decor
• Quiet operation
• Quick and flexible installation for all types of construction 10-1/4" 16" 5-7/8"

PowerHeat™ Series BHFLED80, BHFLED110
• Heater/Fan/Light Heater/Fan, 14-amp circuit acceptable
• Features integrated dimmable LED with color adjustable CCT lighting; warm (2700K), bright (3500K), and daylight (5000K)
• LED dimmable lighting may be used as a nightlight (dimmer switch is not included)

PowerHeat™ Series BHF80, BHF110
• Heater/Fan 14-amp circuit acceptable

BHFLED80F Finish Pack
• Features integrated dimmable LED with color adjustable CCT lighting; warm (2700K), bright (3500K), and daylight (5000K)
• LED dimmable lighting may be used as a nightlight (dimmer switch is not included) Broan

BHFLED80H Housing Pack
• Broan PowerHeat Series Housing pack, 80 CFM
ENERGY STAR® fans use 70% less energy, on average, than standard models and may qualify for local utility rebates


Scan or tap to learn more about the Broan® PowerHeat™ LED Heater Exhaust Fan with CCT LED Lighting.
General Features & Benefits
• Bright white fan cover matches any decor
• 1300-watt heater for instant heat when you want it
• Rugged galvanized steel housing stands up to moisture
• Automatic-reset thermal protection
• Fan, light and heater can operate independently
• Type IC
• Fits in 2x6 ceiling construction
• Two- or three-function wall controls are available separately (see guide on pages 48–51)

• Motor engineered for continuous operation
General Features & Benefits
• Powerful ventilation
• Extra-quiet operation
• Bright ceiling light
• Convenient night light
• White fan cover
• 1500 watts of powerful heat

• Includes a four-function wall switch
• Fits 2x8 ceiling construction

• Efficient PowerHeat™ heater design
• Choose standard E26 base (2, 60 watt) lighting (bulbs not included) or energy-efficient 36 watt GU24 fluorescent (bulbs included)
• Fan motor is engineered for continuous operation
• HVI Certified

• Type IC
• Requires a dedicated 20 amp circuit
• Switches sold separately (see guide on pages 48–51)
• 7 watt night-light (bulb not included)

765H110L
• 1500-watt heater with 360° directionally-adjustable design so heat ends up exactly where you want it
• Bright white fan cover matches any decor
• Select-your-bulb capacity and type (bulb not included)
• Fits in 2x6 ceiling construction
• Rugged galvanized steel housing stands up to moisture
• Motor engineered for continuous operation
Tired of your dirty, discolored old fan cover?
Upgrade your look in 5 minutes.
Broan-NuTone® made upgrading your bath ventilation fan easier than ever. Our convenient upgrades enable you to put a fresh face on an old fan.
See pages 42–47.






Is your fan ready for a new look?
Scan or tap the code to see the complete compatibility cross-reference guide at Broan-NuTone.com

• Quiet, highly efficient blower wheels
• Dampers prevent backdrafts and eliminate mechanical noise
• 4" round duct connectors with tapered sleeves simplify ducting
• Fan and heater can operate independently
• Attractive white fan covers
• Compact steel housings with adjustable mounting brackets with keyhole slots that span up to 24"
• 250 watt R40 or BR40 size infrared bulbs (not included)
• Type IC, UL Listed for 60°C wiring (retrofits)


162, 9417DN While supplies last
• One-Bulb Heater/Fan
General Features & Benefits
• Infrared bulbs deliver energy-saving warmth
• Get instant comfort in the bathroom without turning up the central thermostat
• 250 watt R40/BR40 size infrared bulbs (not included)

164, 9427P While supplies last
• Two-Bulb Heater/Fan, Two-function control
• Attractive, white fan covers
• Compact steel housings
• Adjustable mounting brackets with keyhole slots span up to 24"

161, 9412D While supplies last
• One-Bulb Heater, UL Listed for 75°C wiring

163, 9422P While supplies last
• Two-Bulb Heater, Type IC
*Ventilation Fan/Bulb Heater versions
**While supplies last

A well ventilated room is a healthier room.
Keeping every room in your home fresh is easy and economical. That’s why Broan-NuTone® engineers a ventilation solution to fit every room and budget. Consider a style, finish or shape that complements your room décor. Rest assured, if you’re concerned about saving money and energy, our bath fans are the perfect fit for your room.



• White, fan cover complements any décor
• Fits in 2x6 ceiling construction
• 4" duct / E26 base lighting
• HD80L is designed for continuous operation
• Project packs available for some models
• UL listed for use over tub and shower when installed in a GFCI protected circuit
• HVI Certified

763, 763N, HB80RL
• White, fan cover complements any décor
• Fits in 2x6 ceiling construction
• 4" duct / E26 base lighting
• HB80RL is designed for continuous operation
• Project packs available for some models
• UL listed for use over tub and shower when installed in a GFCI protected circuit
• HVI Certified

• Round design eliminates squaring with walls
• Fits in 2x6 ceiling construction
• 4" duct / E26 base lighting
• 750 feature a regular light and nightlight
• UL listed for use over tub and shower when installed in a GFCI protected circuit
• HVI Certified


696 While supplies last
• White fan covers complements any décor
• Fits in 2x6 ceiling construction
• 4" duct / E26 base lighting
• Designed to fit the space of a heater/fan/light
• UL listed for use over tub and shower when installed in a GFCI protected circuit
**While supplies last

6884H
New housing pack for 688.
The 6884H housing pack consists of 18 housings with 4" duct connectors attached.
Project packs are ideal for contractors and builders who have yet to pick out the final product.

671, 688
• White fan cover complements any décor
• Fits 2x4 ceiling construction
• 3" duct
• Metal fan cover kits available (sold separately)
• Project packs available for most models
• UL listed for use over tub and shower when installed in a GFCI protected circuit
• HVI Certified

E050, E070
• White fan cover complements any décor
• Fits 2x4 ceiling construction
• 3" duct
• Metal fan cover kits available (sold separately)
• Project packs available
• UL listed for use over tub and shower when installed in a GFCI protected circuit
• HVI Certified

696N
• White fan cover complements any décor
• Fits 2x4 ceiling construction
• 3" duct
• Metal fan cover kits available (sold separately)
• Project packs available for most models
• UL listed for use over tub and shower when installed in a GFCI protected circuit
• HVI Certified
Ductless ventilation made simple
Ductless Bathroom Exhaust Fan with snap-in mounting and replaceable charcoal filter processes air to eliminate odors where ductwork is impossible or impractical. It is an easy to install solution for half baths or where humidity isn’t a concern. Included is a long lasting, easy to replace charcoal filter. The easy snap-in mounting makes for a fast and simple installation.

682
Broan Model Duct Cover Size
682 Duct-free 81⁄2 x 81⁄2
Duct Free 3-3/4"
7-1/8" 7-1/8"

Scan to join Broan-NuTone in supporting severely wounded veterans and their families.
We believe that Veterans who have risked their lives daily and return from service severely wounded deserve a better life and a home that meets their physical needs. As a result, we are pleased to support the Gary Sinise Foundation and their R.I.S.E. Program, which builds specially adapted smart homes that serve to restore independence and support the empowerment of these Veterans and their families. At Broan-NuTone, we are proud to donate our products to help improve the air for Veterans so they breathe fresh, clean air in their new forever home. Broan-NuTone.com




Fan upgrade
If you have 5 minutes, it’s easy to make a tired old fan new again.
Broan-NuTone® made upgrading your bath ventilation fan easier than ever. In a matter of minutes, our convenient kits enable you to put a fresh face on a reliable fan, add lighting, a Bluetooth® wireless speaker, or even a performance kit to reduce sound by up to 50%. Upgrade fan covers don’t require any tools for installation. For performance kits, all you need is a flat head screwdriver. It’s another fresh idea for fresher air.

SURFACESHIELD™ FG1000VV
• SurfaceShield™ LED light powered by Vyv™ prevents bacteria, mold, and fungi growth within your room
• SurfaceShield™ technology combined with Broan’s powerful ventilation is an effective one, two punch to kill* viruses and prevent the growth of bacteria, mold, and fungi within your room
• Bright white finish matches most white ceiling paint
• Quickly and easily installs in under 5 minutes
• No cutting required—covers existing drywall cuts
• No additional wiring needed, plugs directly into existing lighting connection
• Compatible with existing ventilation fan housing dimensions of 91⁄4" x 10" (lighted fans only)
• Works with certain legacy Broan or NuTone InVent® , Flex Series™, or Roomside Series lighted exhaust fans
• NOTE: Due to certain State regulations this product is not available in Indiana and Hawaii.
• Fan cover dimensions: 121⁄4" x 121⁄4 "

CHROMACOMFORT™ FG600RGB
• Quickly and easily installs in under 5 minutes
• Customizable, color changing LED lighting and Bluetooth® wireless speaker to play your favorite music, podcast or news
• No additional wiring needed. Quick-connect plug allows you to upgrade without new wiring, even if the existing cover doesn’t have a light
• Fan cover dimensions: 101⁄4" x 9 3⁄4 "

SURFACESHIELD™ LED MODULE VVLED
• The VVLED upgrade light module is compatible with the following fan models: AE80BL, AEN80BL, AEN80L, AE110L, AEN110L, AE80LK, AE110LK, AE50110DCL, AE50110DCSL
• SurfaceShield™ technology combined with Broan’s powerful ventilation is an effective one, two punch to kill* viruses and prevent the growth of bacteria, mold, and fungi within your room
• Quickly and easily installs in under 5 minutes
For a full list of SurfaceShield™ compatible models scan or tap the code.

FG600RGB*
*4-pack

SENSONIC® FG800SPK
• Quickly and easily installs in under 5 minutes
• Brilliant LED lighting and Bluetooth® wireless speaker to play your favorite music, podcast or news
• No additional wiring needed. Quick-connect plug allows you to upgrade without new wiring, even if the existing cover doesn’t have a light
• Soft LED lighting illuminates darker areas of the bathroom; 600 lumens; 3000K color temperature; rated life of 25,000 hours
• Fan cover dimensions: 101⁄4" x 9 3⁄4 "

SENSONIC® FG800SPKN
While supplies last
• Includes 2 sets of fan cover springs for use with multiple ventilation fan models
• Compatible with existing ventilation fan housing dimensions of 7½" x 7¼" and 8¼" x 8"
• Fan cover dimensions: 11" x 9 3⁄4 "
Sensonic ® speakers with Bluetooth® wireless technology fill your room with rich sound from above. Connect to your phone and bring music, talk or your favorite podcast through the dual high-fidelity speakers at the touch of a button.

CHROMACOMFORT™ SENSONIC® FG800RGB
• Quickly and easily installs in under 5 minutes
• Customizable, color changing LED lighting and Bluetooth® wireless speaker to play your favorite music, podcast or news
• No additional wiring needed. Quick-connect plug allows you to upgrade without new wiring, even if the existing cover doesn’t have a light
• Fan cover dimensions: 101⁄4" x 9 3⁄4 "
Broan Model
FG800SPK* + FG800SPKS
FG800RGB* + FG800RGBS
*4-pack
**While supplies last
NuTone Model Light Speaker Install Time
FG800SPKN* + FG800SPKNS** LED Bluetooth® Speaker < 5 min
ChromaComfort™ LED Bluetooth® Speaker < 5 min





Step 1
Remove the old grille.
Step 2
Match the spring size to your current fan.
Step 3
Snap the springs into the cooresponding clips.
Step 4
Squeeze and insert into the slots.
Step 5
Push it up tight and you're done.



LED LIGHT FG600
• Quickly and easily installs in under 5 minutes
• Brilliant LED lighting illuminates darker areas of the bathroom; 750 lumens; 3000K color temperature; rated life of 25,000 hours
• No wiring needed; quick-connect plug allows you to easily connect the LED light
• No drywall cutting or patching required
• Bright white finish matches most white ceiling paint
• Compatible with existing fan housing dimensions
71⁄4" x 71⁄2" and 81⁄4" x 8"
• Fan cover dimensions: 101⁄4" x 93⁄4 "

• Reduces sound by up to 50% while improving air movement by up to 20%
• 60 CFM adequately ventilates smaller baths and powder rooms
• 2.5 sones provides quiet performance
• White fan cover blends well with any décor
• Fan cover stays cleaner longer with fewer vent slots to clean
• Motor plate accommodates a variety of economy fan models
• Air and sound ratings are HVI Certified
• UL Listed
*

• Quickly and easily installs in under 5 minutes
• Brilliant LED lighting illuminates darker areas of the bathroom; rated life of 25,000 hours
• No wiring needed; quick-connect plug allows you to easily connect the LED light
• No drywall cutting or patching required
• Bright white finish matches most white ceiling paint
• Compatible with existing fan housing dimensions
71⁄4" x 71⁄2" and 81⁄4" x 8"
• Fan cover dimensions: 11" x 93⁄4 "

• Fresh, stylish design to easily revitalize an existing fan cover
• Quickly installs in under 5 minutes
• No drywall cutting or patching required
• Universal Fit for compatibility with small, medium and large size Broan and NuTone ventilation fans
• Bright white finish matches most white ceiling paint
• Low profile seamlessly blends into the ceiling
• Fan cover dimensions: 131⁄8" x 131⁄8 "

• Retrofits InVent® ventilation fan installations
• No drywall cutting or patching
• Hides existing dry wall cuts
• Instant upgrade blends with any décor
• Bright white finish matches most white ceiling paint
• Compatible with existing fan housing dimension of 91⁄4" x 10"
• Fan cover dimension: 111⁄2" x 12"
• Fits Broan® and NuTone® Roomside, Flex Series™ and InVent® Series fans without a light

• Retrofits Economy Series ventilation fan installations
• No drywall cutting or patching
• Hides existing dry wall cuts
• Instant upgrade blends with any décor
• Bright white finish coordinates with most white ceiling paint
• Compatible with existing fan housing dimension of 7½" x 7¼"
• Fan cover dimension: 9¼" x 9¾"
• Fits Broan® and NuTone® Economy Series fans

• Heater exhaust fan light upgrade
• Features integrated dimmable LED with color adjustable CCT lighting; warm (2700K), bright (3500K), and daylight (5000K)
• LED dimmable lighting may be used as a nightlight (dimmer switch is not included)
• Bright white finish matches most white ceiling paint
• Compatible with: Broan 655 revision C (units manufactured after the year 2001), NuTone 665RP, Broan 656, Broan 659, Broan 657, Broan 696, NuTone 668RP, NuTone 765H80L, & Broan 765H80LB.
• Fan cover dimensions: 93⁄4" x 161⁄4 "

• Heater exhaust fan light upgrade
• Features integrated dimmable LED with color adjustable CCT lighting; warm (2700K), bright (3500K), and daylight (5000K)
• LED dimmable lighting may be used as a nightlight (dimmer switch is not included)
• Bright white finish matches most white ceiling paint
• Compatible with: Broan 100HL, Broan 100HFL, NuTone 765HL, Nutone 765HFL, NuTone 765H110L, and Broan 765H110LB
• Fan cover dimensions: 113⁄4" x 173⁄4 "
The perfect control switch is a beautiful finishing touch, and our attractive options provide the speed, sensing and control needed for any spot ventilation solution. Sleek styles in bright white complement all designs and color palettes. All you need is the faceplate to match your décor. Installation is simple, and the results will help you breathe easy.





Humidity Sensing Controls
Sensaire™ Humidity Sensing Switch Models 82W*
• Turn any ventilation fan into a humidity-sensing solution
• Up to 4X faster humidity sensing than the competition
• Helps reduce mold and mildew to improve indoor air quality
• Three easy-to-program modes: Auto Sense Mode, Duty Cycle Mode & RH% Humidistat mode
• Rated 120V at 60Hz, max total of 9 amps/switch
• Available in Ivory (V) or White (W)
Digital Dehumidistat Model DD500W*
• Turn any ventilation fan into a humidity-sensing solution
• Reduce mold and mildew to improve indoor air quality
• Precision control enables desired humidity level to start the fan
• LED indicates fan on/off status
• Rated 120V at 60Hz, max total of 9 amps/switch
• Replaces obsolete model DH100W


Model P2RW*
• Two rocker switches control any two functions: fan, light, heater or nightlight
• Save space, conveniently fitting in a single gang box
• Simple installation saves time and money
• Rated 120V at 60Hz, max total of 15 amps/switch
• Replaces obsolete models: 269VL, 269WL, 68V, 68W, P68W, P68WN





Model P3RW*
• Control multiple applications from a single, central location
• Control any exhaust fan, fan/light or heater/fan/light
• Save space, conveniently fitting in a single gang box
• Simple installation saves time and money
• Rated 120V at 60Hz, max total of 15 amps/switch
• Replaces obsolete models: 66V, 66W, P66V, P66W, P66WN


Model SC100W*
• Turns any PSC or AC fan into an adjustablespeed fan
• Control sound levels by adjusting fan speed and CFM power
• Adjust fan speed precisely to bathroom ventilation needs to save energy
• Rated 120V at 60Hz, max total of 3 amps/switch
• Replaces obsolete models: 277V, 57V, 57W, 75V, P57W, P57WN

Model MS100W
• Turn fan on/off when motion is sensed or stops
• Set fan/light runtime after motion stops
• Detect motion in rooms up to 900 square feet
• Sense motion up to 35 feet away
• Save energy by operating the fan/light only when motion is detected
• Rated 120V at 60Hz, max total of ½ HP, 300W LED/ CFL, 600W incandescent


Model CD60W*
• Set countdown timer to 20, 40 or 60 minutes
• Can also be set to run continuously
• Save energy—countdown timer ensures the fan always turns off
• LED indicates run-time remaining
• Rated 120V at 60Hz, max total of 9 amps/switch
• Replaces obsolete models: 59V, 59W, 61V, 61W, 62W, 63V, 63W, 71V, CFT12WH, P59V, P59W, P59WN, P61WN, VS63WH, VS66WH, VS67WH, VS68WH, VS69WH
Models DT100W*
• Use the ‘delay’ setting under the switch plate to ensure proper bathroom ventilation by keeping the fan running for 5 to 60 minutes after you leave
• Use the ‘ventilation’ setting to meet code requirements by ventilating the bathroom for a predetermined amount of time every hour
• User adjustable settings can be changed as much as desired until the perfect setting is found
• Designed to meet ASHRAE 62.2 and CalGreen Title 24 codes for continuous ventilation
• Rated 120V at 60Hz, max total of 6 amps/switch
• Replaces obsolete models: 64V, 64W

Precisely control the ventilation in your bathroom or indoor environment to mitigate mold and moisture issues from improper use of exhaust fans. Make Sensaire™ your first choice in smart ventilation.
670, 671, 688, 689
Ventilation Fans
Ventilation Fan/Lights
E050, E070
LP80, LP110
LP50100DC
AE50, A80, A80HD, AE80, AE80B, A110, AE110, AE80K, AE110K
AE80S, AE110S
AE50110DC
AE50110DCS
QTXE080, QTXE110, QTXE150
QTXE110S
QTXE110150DC
QTXE110150DCS
RB80, RB110
XB50, XB80, XB110
XB110H
ZB80, ZB110
ZB80M, ZB110M
657, 678, 679, 696, 751, HD80L
744, 744LED, 744L, 744RL
A50L, A70L, A80L, AE80L, AE80BL, A110L, AE110L, AE80LK, AE110LK
AE80CCTK, AER110CCTK
AE80SL, AE110SL
AE50110DCL
AE50110DCSL
770RLTK, AR80LWH, AER80LWH, AER110LTK, AER110LBN
AER110SLW
AR80MB
QTXE080FLT, QTXE110FLT, QTXE150FLT
QTXE110150DCL
QTXE110150DCSL
RB80L1, RB110L1
XB50L1, XB80L1, XB110L1
ZB80L1, ZB110L1
ZB80ML1, ZB110ML1
Heater/Fan/ Lights 765H80LB, 765H110LB
100HL, 100HFL
BHFLED80, BHFLED110, BHF80, BHF110
QTX110HL, QTX110HFLT
Products in red have been discontinued.
*The CD60W will work with these heater/fan/lights if the heater is wired to a separate rocker switch
Ventilation Fans
Ventilation Fan/Lights
695, 696N
EZ80N, LPN80
AEN50, AEN80, AEN80B, AN110, AEN110, AERN80K, AERN110K
QTXEN080, QTXEN110, QTXEN150
RN80, RN110
668RP, 763, 763N, 8664RP, HB80RL
8663RP
744NT, 744LEDNT, 744RNL
AN70L, AN80L, AEN80L, AEN80BL, AN110L, AEN110L, AERN80LK, AERN110LK
AERN110DCSL
770RNLTK, AERN80LWH, AERN110LTK
AERN110SLW
QTXEN080FLT, QTXEN110FLT, QTXEN150FLT
QTNLEDA, QTNLEDB
RN80L, RN110L
765H80L, 765H110L
Heater/Fan/ Lights
765HL, 765HFL
9093WH, QT9093WH
QTXN110HL, QTXN110HFL
Products in red have been discontinued.
*The CD60W will work with these heater/fan/lights if the heater is wired to a separate rocker switch

MERV Filtration
In today’s tightly built homes, bringing fresh air inside makes perfect sense, whether it’s done to meet code requirements or for personal comfort preferences.
That’s why Broan offers Basic and Premium solutions to residential ventilation. Both models have variable speeds and an ultra-efficient Electronically Commutated Motor (ECM) to maintain a constant airflow. The Basic model is a single-mode solution that delivers continuous airflow. The Premium model utilizes an algorithm that satisfies three ventilation codes and offers five comfort modes to suit different climatic environments. Built-in intelligence delivers airflow without losing efficiency when installed according to industry best practices.
An open window doesn’t mean fresh air. The moment you open a window, fine dust and other allergy aggravating particles settle onto every surface. Optional MERV 8 or MERV 13 rated filters remove particulates before air enters the dwelling.



• High efficiency ECM motor lowers energy consumption for more savings
• Blower efficiency as high as 8.4 CFM/W
• Constant airflow maintains the selected airflow under any conditions (up to 0.55 in. w.g.)
• Small and lightweight for easy installation and service
• Super silent ventilation with a sound level of 0.65 @ 130CFM
• High density EPS insulated housing avoids condensation and air leakage
• 5-year parts warranty
Broan Fresh In™ fits in, anywhere. Install in any location or orientation—from the attic to the basement.


Optional VT11W Wall Control for Fresh In™ Premium features a filter clean indicator light.

Comfort modes
**The intelligent Fresh In™ algorithm is patent pending.


Every room needs ventilation. That’s why we thought of every solution. Our utility fans deliver clean, fresh air wherever you need it—a bathroom, laundry room, recreation room, workshop or nursery. Look to our room-to-room, wall/ceiling mount, through-wall or vertical discharge utility fans for powerful spot ventilation. Simple, practical and powerful—our fans provide the quality you expect and the comfort you deserve.

General features for chain-operated utility fans
• Pull-chain opens the door and starts fan
• Housing adjusts to fit walls from 4½"–9½" thick
• Specially designed fan blade
• Housing features foam insulated door for energy efficiency
• Use for a garage, kitchen, laundry room, rec room, and more


506 507
• 10" fan (103⁄8" diameter sleeve)
• 430 CFM, designed for use in a garage, kitchen, laundry room, rec room, and more
• 7.5 Sones
While supplies last
• 8" fan (83⁄8" diameter sleeve)
• 250 CFM
• 7.0 Sones

502 While supplies last, 503
• Installs easily between ceiling joists or wall studs
• Built-in damper prevents backdrafts
• Fits 31⁄4" x 10" duct
• 502 is 300 CFM and 503 is 160 CFM
• 502 is 9.0 Sones and 503 is 5.0 Sones
General features for room-to-room fans
• Adjustable mounting brackets span up to 24 in.
• Installs easily between ceiling joists or wall studs
• Built-in damper prevents backdrafts
• Bright white fan cover matches most white ceiling paint
• Permanently lubricated, thermally protected motor
• UL listed and HVI-2100 certified for safety

510
While supplies last
• 370 CFM, Whole home or Commercial Ventilation
• 8.5 Sones
511
• 180 CFM, powerful ventilation designed for larger rooms or master baths, eliminates moisture, pollutants, and odors from larger rooms
• 4.5 Sones

508 (10"), 509/509S (8")
• 509S: features an integral ON/OFF rotary switch–no wall switch to wire
• 509S: use in a garage, kitchen, laundry room, rec room, and more
• 508 is 290 CFM and 7.5 Sones
• 509/509S is 200 CFM and 8.5 Sones
**While supplies last

512 While supplies last
• 90 CFM, Powerful ventilation to remove moisture and reduce the risk of mold or mildew
• 4.0 Sones
• Built-in variable speed control
• Easy interior wall installation
• Galvanized steel housing stands up to moisture
• Permanently lubricated motor
• 6" room to room
• Use SC100W speed control separately
• Galvanized steel housing installs easily between ceiling joists
• Steel mounting brackets with keyhole slots for fast installation

504
While supplies last
• 10" vertical discharge
• Fits 10" round duct–use Model 472 transition/ damper (available separately) for 8" round duct (performance will be reduced)
• 330 CFM and 8.0 Sones
505
• 8" vertical discharge with built-in damper
• 8" fan, 8¼" diameter housing
• 200 CFM and 8.5 Sones

512M
• 6" Through-Wall
• Louvered exterior wall cap with built-in bird screen
• 6" diameter flexible aluminum duct included
• 70 CFM and 6.0 Sones 673

While supplies last
• 6" vertical discharge with built-in damper
• 6" paintable fan, spin-on, white fan cover
• 60 CFM and 4.5 Sones
**While supplies last

8210 Ceiling Mount, Vertical Discharge
While supplies last
• Ventilates directly through the roof with round ducting
• 210 CFM, Whole home or Commercial Ventilation
• 6.5 Sones
• Surface-mount fan installs on interior walls with ease
• Room-to-room wall fan
• Two attractive white fan covers can be painted to match decor
• High-strength, reinforced fan blade
• Permanently lubricated motor for a long life
• Specially designed housing reduces diameter of discharge opening to fit 7" round duct; no reducer needed
• UL Listed for use in cooking areas

8310 Wall/Ceiling Mount, Side discharge only
While supplies last
• 160 CFM, powerful ventilation designed for larger rooms or master baths, eliminates moisture, pollutants, and odors form larger rooms
• 5.0 Sones
• Steel mounting brackets with keyhole slots for fast installation
• Duct size 8" diameter
• 3¼" x 10" duct, side discharge
• Installs easily in walls or ceiling
• Built-in backdraft damper
• UL Listed for use in cooking areas
**While

Broan-NuTone® is America’s most trusted residential ventilation company. We’re proud to bring better air quality to more than 90 million homes nationwide.

Need an exceptionally quiet solution to light commercial ventilation? With their heavy-duty motors, Broan-NuTone High Capacity Ventilation Fans are the perfect answer for ventilating conference rooms, dining areas, public restrooms and other heavily-trafficked spaces.
Low-vibration and low-profile, these discrete products work quietly and powerfully behind the scenes to remove odor, humidity and air-borne particulates that affect indoor air quality.

L100E, L150E, L200E, L250E, L300E
Available end of 2022
• Ceiling mounted
• 8" round metal duct connector
• 20 gauge galvanized steel housing
• Duct horizontally or vertically
• Low profile, white plastic fan cover
• Model MG1 metal fan cover sold separately
• Models L100E, L150E, L200E, L250E and L300E are cULus listed for use over tubs and showers when connected to a GFCI branch circuit
• Model 80L Variable Speed Control adjusts blower speed and sound level (available separately)

L100EL, L150EL, L200EL, L250EL, L300EL
Available end of 2022
• Inline mounted
• Removable access panel, no insulation
• Two 8" round duct connectors
• No fan cover
• Suitable for kitchen installations
11-3/4"
12-1/4"
12-1/4"

L100, L150 L200, L250, L300
• 6" round metal duct connector
• Single, impact-resistant centrifugal blower wheel housing
• 20 gauge galvanized steel housing
• Duct horizontally, vertically, or in-line with a separate adapter
• Low profile, white or painted white enamel metal fan cover
• Models L100L and L150L are UL Listed for use over tubs and showers when connected to a GFCI branch circuit
• Model 80L Variable Speed Control adjusts blower speed and sound level (available separately)
• 8" round metal duct connector
• Single, impact-resistant centrifugal blower wheel (Model L300KMG has a metal wheel)
• 20 gauge galvanized steel housing
• Duct horizontally, vertically, or in-line with a separate adapter
• Models L200L, L250L and L300L are UL Listed for use over tubs and showers when connected to a GFCI branch circuit
• Model 80L Variable Speed Control adjusts blower speed and sound level (available separately)

L400, L500, L700
•
•
•
• Quiet automatic backdraft dampers

L100L, L150L L200L, L250L, L300L
• Removable access panel, no insulation
• Two 6" round duct connectors
• No fan cover
• Suitable for kitchen installations
• Removable access panel, no insulation
• Two 8" round duct connectors
Model MG1 Metal Fan Cover Upgrade
Compatible with L100, L150, L200, L250 and L300 series ventilation fans. Installation can be completed in 5 minutes or less

Model 80L Variable Speed Control
Specially designed for use with Broan LoSone Select ® ventilators rated at 3 Amps or less

Model RD1
Radiation Damper
Prevents the rapid spread of fire to other areas of a home during a fire

VENTILATION IN COMMON AREAS WHEN YOU NEED IT

L400L, L500L, L700L
• Removable access panel; no insulation

L900L, L1500L
• Removable access panel; no insulation
• Can use the 80L variable speed blower control (sold separately)

L900, L1500
• L900 can use the 80L variable speed blower control (sold separately)

L2000L
• 38"L x 145⁄8"W x 145⁄8"H
• Fits 73⁄4" x 333⁄4" duct
• Optional metal fan cover (Model G102) and damper kit (Model D100)
Model S437
• High-capacity design up to 1200 CFM
• Built-in bird screen
• Steel housing, black electrically bonded epoxy finish
Model 611**
• For flat roof installation
Model SLAF1
• Aluminum mesh filter traps grease and protects motor
• Dishwasher safe

• Aluminum natural finish
• For up to 8" round duct
Model 611CM**
• For curb mount installation
• Other features same as Model 611
Model 612**
• For flat roof installation
• Aluminum natural finish
• For up to 12" round duct
Model 612CM
• For curb mount installation
• Other features same as Model 612
Model 634
• For 31⁄4" x 10" or up to 8" round duct




• Built-in backdraft damper and bird screen
• Steel housing, black electrically bonded epoxy finish
Model 634M
• Same as Model 634, except for 6" round duct
Model 644**
• Same as Model 634, except aluminum natural finish

• SLAF1 (12" x 12") for L100/150/200/250/300 Series
• SLAF1 for use with metal covers
Model 441
• For 10" round duct
• Steel with aluminum louvers
Model 613**
• For 12" round duct
• Built-in backdraft damper and bird screen


• Aluminum natural finish
Model 641
• Same as Model 613, except for 6" round duct
Model 643
• For 8" round duct
• Built-in backdraft damper
• Aluminum natural finish
Model 843BL
• For 6" round duct
• Built-in backdraft damper and bird screen
• Black finish


Model 961L**
• For L100/L150 Series
• Galvanized steel
• 6" round duct intake
Model 981L**
• For L200/L250/L300 Series
• Galvanized steel
• 8" round duct intake
Model 982L**
• For L400/L500/L700 Series
• Galvanized steel
• 41⁄2" x 181⁄2" duct intake
Model 983L**

• For L900/L1500 Series
• Galvanized steel
• 8" x 12" duct intake

Models S423 & ST81212
• Galvanized steel
• S423: (41⁄2" x 181⁄2" to 10" round)
• ST81212: (8" x 12" to 12" round)

Model V104** (not shown)
• For Model L2000L
• Heavy gauge steel construction
• Neoprene vibration dampening cushion
• Maximum load 75 lbs (each)
• For 3⁄8" diameter threaded rod (available separately from others)
• Set of four required for each ventilator
Model MG1
• For L100/150/200/ 250/300 Series
• White enamel painted steel
• Mounting screws included
When excessive heat is detected, the breakaway fusible link triggers the closing of the radiation damper’s fire resistant screen to prevent smoke and fire from traveling through ductwork.
• 165° fusible link
• Galvanized steel frame
• Stainless steel negator-type closure spring

High Capacity Models RD1, RD2, RD3 (not shown)
• UL rated 3-hour ceiling radiation dampers
• High temperature, non-asbestos, reinforced fiber thermal fabric
• RD1 (121⁄2" x 121⁄2") for L100/150/200/250/300 Series
• RD2 (213⁄4" x 121⁄2") for L400/500/700 Series
• RD3 (221⁄4" x 181⁄4") for L900/1500 Series

Model DD500W*
• Turn any ventilation fan into a humidity-sensing solution
• Reduce mold and mildew to improve indoor air quality
• Precision control enables desired humidity level to start the fan
• LED indicates fan on/off status
• Rated 120V at 60Hz, max total of 9 amps/switch
• Replaces obsolete model DH100W

Model P2RW*
• Two rocker switches control any two functions: fan, light, heater or nightlight
• Save space, conveniently fitting in a single gang box
• Simple installation saves time and money
• Rated 120V at 60Hz, max total of 15 amps/switch
• Replaces obsolete models: 269VL, 269WL, 68V, 68W, P68W, P68WN

Model 80L
• Adjust ventilation easily in any room
• Variable Speed Control mounts inside the fan housing and enables blower speed adjustment
• For Broan High Capacity Fans L100–L900
• Speed control with metal housing
• Perforated fan insulation for easy installation
• 120V, 3 amps, 60 Hz
*Faceplate not included

Model CD60W*
• Set countdown timer to 20, 40 or 60 minutes
• Can also be set to run continuously
• Save energy—countdown timer ensures the fan always turns off
• LED indicates run-time remaining
• Rated 120V at 60Hz, max total of 9 amps/switch
• Replaces obsolete models: 59V, 59W, 61V, 61W, 62W, 63V, 63W, 71V, CFT12WH, P59V, P59W, P59WN, P61WN, VS63WH, VS66WH, VS67WH, VS68WH, VS69WH

Model DT100W*
• Use the ‘delay’ setting under the switch plate to ensure proper bathroom ventilation by keeping the fan running for 5 to 60 minutes after you leave
• Use the ‘ventilation’ setting to meet code requirements by ventilating the bathroom for a predetermined amount of time every hour
• User adjustable settings can be changed as much as desired until the perfect setting is found
• Designed to meet ASHRAE 62.2 and CalGreen Title 24 codes for continuous ventilation
• Rated 120V at 60Hz, max total of 6 amps/switch
• Replaces obsolete models: 64V, 64W



Prevent heat and moisture build-up. Attics can reach over 150°F in summer, warming your living area, increasing the air-conditioning load and your energy bill. In winter, ice dams can form, and moist air can condense causing mildew, rotting wood and wet insulation. Year-round attic ventilation ensures a cooler, drier attic which can extend the life of your roof and air conditioner, while lowering air conditioning expense.


• Reduces moisture in attic
• Lowers temperature of home in summer
• Metal flashing allows for nailing and hot tar application
• Mesh bird screen

356BK
• Built-in adjustable thermostat for automatic operation at your chosen temperature
• Mounts easily between rafters, installation template included

353, 35316 While supplies last
• Galvanized steel housing for added strength
• Combine with automatic shutter (model 433) to get optimum efficiency and performance

DD500W
Remote In-Line Ventilator
Turn any ventilation fan into a humidity-sensing solution. Reduce mold and mildew to improve indoor air quality. Precision control enables desired humidity level to start the fan.
**While supplies last
For most roofs, our onepiece solar-powered attic ventilator (SPAV) is the perfect solution. Because our solar cells are highly efficient at capturing the sun’s energy, there is no need for unsightly raised panels or tracking systems. Instead, what you see is a low profile ventilator in a contoured design that integrates well with the roof.




433
Automatic Shutter for Gable Mount
Attic Ventilators
While supplies last
Feature counter-balanced aluminum vanes that automatically open and close when the ventilator turns on and off
Better air flow than stationary attic louvers
Extruded aluminum frame fits flush with outside wall
Weather-tight closure
Easy to install
For use with Broan Models 353 and 35316.
**While supplies last
Model 406 Round Duct**
• 6" round duct
• 2' galvanized section
Model 407 Round Duct**
• 7" round duct
• 2' galvanized section
Model 410 Round Duct
• 10" round duct
• 2' galvanized section
Model RVK1A†
Flexible Roof Ducting Kit
• Includes Model 636 Roof Cap
• 4" diameter metal duct connector
• 2 duct clamps
• 4" to 3" reducer
• 8' of 4" flexible aluminum ducting
Model WVK2A†

Flexible Wall Ducting Kit
• Includes white polymeric wall cap
• 4" diameter metal duct connector
• 2 duct clamps
• 4" to 3" reducer
• 5' of 4" flexible aluminum ducting
Model 418
Adjustable Elbow
• Fits 10" round duct

Model 99010042 Aluminum Filter
• Fits Utility Ventilator
Models 503, 503MG, 505, 505MG, 509, 509MG, 509S and 509SMG

Model 99010271 Aluminum Filter
• Fits Utility Ventilator
Models 12C, 12CMG, 502, 502MG, 504, 504MG, 508, 508MG, 510, 510MG, 511 and 511MG
Model S437 10" Round†

• High-capacity design up to 1200 CFM
• Backdraft damper and built-in bird screen
• Welded steel construction
• Black powder coat finish
Model 611 Roof Cap†**
• For flat roof installation
• Aluminum natural finish
• For up to 8" round duct
Model 611CM Roof Cap†**
• For curb mount installation
• Other features same as Model 611
Model 612 Roof Cap†**
• For flat roof installation
• Aluminum natural finish
• For up to 12" round duct
Model 612CM Roof Cap†**
• For curb mount installation
• Other features same as Model 612
Model 634 Roof Cap†
• For 31⁄4" x 10" or up to 8" round duct
• Black powder coat finish
• Backdraft damper and bird screen
• Welded steel construction





†Not for use with dryers
**While Supplies last
Model 634M Roof Cap†
• Same as Model 634 except for 6" round duct
Model 636 Roof Cap†
• For 3" or 4" round duct
• Built-in backdraft damper and bird screen
• Black powder coat finish
• Welded steel construction


Model 636AL Roof Cap†**
• Same as Model 636, except aluminum natural finish
Model S413 Transition
• Converts 31⁄4" x 10" duct to 8" round duct
Model 463B Transition**
• 3–4" duct expander
Model 465B Transition**
• 4–5" duct expander

Model 613 Wall Cap†**
• For 12" round duct
• Built-in backdraft damper and bird screen
• Aluminum natural finish
Model 639 Wall Cap†
• For 31⁄4" x 10" duct
• Spring-loaded backdraft damper
• Built-in bird screen
• Black powder coat finish
• Welded steel construction
Model 641 Wall Cap†
• For 6" round duct
• Spring-loaded backdraft damper
• Built-in bird screen
• Aluminum natural finish



• Model 647 for 7" Round duct
Model S647 Wall Cap†
• For 7" round duct
• Other features same as Model 641
Model 649 Wall Cap†**
• Same as Model 639, except aluminum natural finish
Model 843BL Wall Cap†
• For 6" round duct
• Built-in backdraft damper and bird screen
• Black powder coat finish
• Welded steel construction



Model 885BL Wall Cap†
• For 3" or 4" round duct
• 4" to 3" transition included
• Black powder coat finish
• Standard package—6 to a carton

• Spring-loaded backdraft damper
• Built-in, welded bird screen
• Welded steel construction
Model 885AL Wall Cap†**
• Same as model 885BL except aluminum natural finish
Model 642
• For 4" round duct
• Aluminum natural finish
• 4 to a carton
Model 643 Wall Cap†
• For 8" round duct
• Aluminum natural finish


• Backdraft damper, no bird screen
Model 646 Louvered Wall†** Cap for 6" Round Duct
• Single pack
• White polymeric
Model WC650 Wall Cap†**
• For 4" round duct
• White polymeric
• 4 to a carton

†Not for use with dryers
**While supplies last
*Bulb not included.
Radiation Dampers can be found on pages 14 and 61. *With 6" duct (with 4" duct 0.3).
See models 162 and 164 above for Ventilation Fan/Bulb Heater versions
**While supplies last
**While supplies last
LIGHT COMMERCIAL
AE50 (Ceiling Mount)
L150 Series (Ceiling Mount)
For In-line models, performance listed is for straight-through ducting at .125" static pressure. For complete sones and CFM at other static pressures, see our Web site at www.Broan-NuTone.com.
Broan-NuTone® is America’s leading brand of residential ventilation products including range hoods, ventilation fans, fresh air systems, and automated whole home indoor air quality monitoring and ventilation system.


Moisture in the bath can damage a home’s structure, and unpleasant air can spoil a home’s environment. Enjoy peace of mind knowing bathroom moisture and unpleasant air is quietly being removed by ULTRA Pro. Engineered to provide efficient and quiet operation, ULTRA Pro fans protect a home and its occupants by removing unwanted air indoors, while
SEALINGTIGHTtoblockoutdoorairfromflowingin.


Protection. Serenity. Delivered by ULTRA Pro.

QUIETLY IMPROVING INDOOR AIR QUALITY FOR A HEALTHIER, MORE RELAXING EXPERIENCE.
Moisture in the bath can damage a home’s structure, and unpleasant air can spoil a home’s environment. Enjoy peace of mind knowing bathroom moisture and unpleasant air is quietly being removed by ULTRA Pro. Engineered to provide efficient and quiet operation, ULTRA Pro fans protect a home and its occupants by removing unwanted air indoors, while SEALING TIGHT to block outdoor air from flowing in.
Available in both lighted and unlighted models, ULTRA Pro fans are designed to be efficient, quiet and easy to install. CLASSIC

RB80
RB110

RB80L1
RB110L1
QFlow™
Technology delivers smoother airflow and superior backdraft seal
• W ith fan off, QFlow damper seals tightly to block outdoor air from flowing inside
• W ith fan on, QFlow damper lifts air out of path to reduce static pressure and noise, while maximizing airflow

Broan.com
QStream™ Sound Technology reduces sound levels and improves overall sound quality
• QStream uses a patented baffle system to smooth the flow of air, reducing noise from turbulence
• QStream Technology allows the blower to run more slowly and quietly
ULTRA Pro fans are engineered to deliver the fastest, easiest and most universal installations
• Expandable mounting frame adjusts to fit any type of joist, I-joist or truss construction
• System works in new construction or room-side retrofit installations
High-power, dual LEDs provide superior light intensity
• Dimmable LED can be adjusted to illuminate the room or provide a soft night light
• Long-life LEDs last up to 10,000 hours
For multi-family applications, accessory radiation dampers RDFU and RDFUWT are available to fit any ULTRA models. Visit broan.com for application details.
Broan, 926 W. State Street Hartford, WI 53027 800-558-1711 In Canada call 877-896-1119


Not all homeowners recognize what contributes to poor indoor air quality, the potential effects and harm, and how to address these problems. Broan-NuTone® is here to help. For nearly 90 years, Broan-NuTone has led the industry with residential ventilation solutions that improve indoor air qualityandprovidehealthierhomeenvironments





removes cooking effluents during food preparation to eliminate airborne pollutants from spreading through the entire house.

efficiently exchange
inside air with fresh outside air, and remove airborne particulate with HEPA filtration.

removes excess moisture and odor from any room in the home, and can also provide continuous, whole-house ventilation.
Broan-NuTone can improve indoor air quality in every room of the home. From clearing humidity in the bathroom to removing steam and other airborne effluents in the kitchen, no company knows residential and light commercial ventilation like Broan-NuTone. After countless innovations and a commitment to indoor air quality, trust Broan-NuTone to clear up every concern.
Not all homeowners recognize what contributes to poor indoor air quality, the potential effects and harm, and how to address these problems. Broan-NuTone ® is here to help. For nearly 90 years, Broan-NuTone has led the industry with residential ventilation solutions that improve indoor air quality and provide healthier home environments.

Moisture that is not properly ventilated can cause mildew and mold formation, potentially leading to structural and health problems.
Exhaust ventilation solutions from Broan-NuTone remove humidity at the source to help maintain the optimal humidity balance of 40–60%.

Off-gassing from construction materials, carpeting, adhesives and synthetic materials—as well as solvents from common household cleaners—can accumulate in tightly built homes. Look to Broan-NuTone for continuous ventilation solutions that meet ASHRAE 62.2.

Particulates from dust, allergens, pet dander, and more can contribute to poor indoor air quality up to 100

Cooking
America’s most used and trusted residential ventilation company. Broan-NuTone is proud to have our American-made ventilation and home comfort and convenience products installed in 90 million homes across the country.




The fact is, the kitchen is a primary source of poor indoor air quality. Excessive moisture, smoke, and air-borne particulate quickly infiltrates every room in your home. Indoor air can be up to 100 times more polluted than outside air, which means adequate ventilation is critical to a more comfortable and healthier environment. Broan has performance matched ventilation solutions for every cooking style and the type of appliance beneath it. Whether it’s a focal point in your kitchen, or concealed in custom cabinetry, trust Broan—the leader in residential ventilation—to provide the optimal solution.
The best solution for faster smoke and odor removal.
A microwave oven has its purpose. And so does a range hood. While it may seem like you’re tackling two problems with one appliance, there’s always give and take. The ventilating capability of an over-the-range microwave simply doesn’t compare to Broan kitchen ventilation. The purposeful design of Broan range hoods allows faster, more effective removal of smoke, odors and particulates for improved indoor air quality, and a cleaner kitchen.
The Broan Captur™ Ventilation System ensures unsurpassed performance. When we set out to improve every aspect of kitchen ventilation, removing heat, smoke and moisture was key. After all, according to the EPA, the kitchen is one of the primary sources of indoor air quality problems—capturing and removing cooking effluents at the source is critical. So we looked at everything, inside and out. The blower wheel and motor assembly are designed to move more air with greater efficiency, unique filters capture effectively without restricting airflow, and new hood shapes provide effective coverage over all burners. All of which mean better performance, quieter operation and less energy use.





 Shown: Sahale range hood featuring the Captur™ system with three pots boiling, versus a microwave with two pots boiling.
Shown: Sahale range hood featuring the Captur™ system with three pots boiling, versus a microwave with two pots boiling.
The right range hood and accessories for your cooking style, design sense, and easy installation.


Chimney Hoods. Do you have an open-concept kitchen?
Consider a chimney style range hood to create a stunning focal point. Choose wall-mounted designs or a suspended range hood over an island cooktop. Be sure the blower you select matches the BTU output of your range.

Under Cabinet Hoods. In need of power while preserving cabinet space?
The under cabinet range hood is the most popular type. You’ll also find great styles in appliance-matching finishes, different performance levels and attractive price points.

Downdrafts. Looking for a range hood that’s there when you need it and hidden when you don’t?
Downdraft range hoods are perfect for island or peninsula installations. You receive the right amount of ventilation literally at the push of a button.

High Performance Hoods. Looking for convenience in a high performance range hood?
Style, power and modern convenience are possible with high-performance hoods. Highly effective filtration and stainless steel bottoms make cleaning easy. Just match your blower to the BTU output of your range.

Power Pack Inserts. Thinking of designing custom cabinetry?
Power pack inserts allow you to conceal your range hood inside a cabinet for a clean look. Insert a power pack and achieve all the benefits of great ventilation.

Every room deserves a focal point. In the kitchen, achieve it with Broan Chimney & Island range hoods. Strong angles, gentle curves, glass accents, striking lighting. Details make all the difference, and that says something about you.
Shown: EW54 on page 17






This beautiful, traditional European design brings an exciting new look to your kitchen. Quiet operation and bright LED lighting enhances your cooking experience, while the sleek 3-speed capacitive touch control makes operation and clean-up easy.
• Quiet 460 MAX Blower CFM operates at a best-in-class 1.5 sones at normal speed.
• Bright 2-level LED module (included).
• Tap-touch, three-speed capacitive control features a smooth, easy-to-clean surface.
• Dishwasher-safe deluxe filters feature quick-release latch for easy removal.
• CRT provides the ability to meet codes and reduce airflow to 300 CFM.
• 10 minute delay-off function keeps hood running after cooking to ensure smoke and odors have cleared the environment.
• O ptional non-duct recirculation kit and filters available.
• Ducted/non-ducted telescopic flue extension accommodates 8' to 9' ceiling heights. Flue extensions available to accommodate ceiling heights from 9' to 10'.
• Installation brackets are included for easy installation.


* M AX Blower CFM indicates hood blower performance in open air. Find HVI rated performance for this model in the product specification sheet at Broan-NuTone.com
† Sones at normal (or working) speed.
Install the hood so that the bottom of the unit is 24" to 30" above the cooking surface. Mounting height may be affected by ceiling height.




Elegant, curved glass design provides a stunning focal point for any kitchen. Quiet operation and bright LED lighting enhances your cooking experience, while the sleek 3-speed capacitive touch control makes operation and clean-up easy.
• Quiet 460 MAX Blower CFM operates at a best-in-class 1.5 sones at normal speed.
• Bright 2-level LED module (included).
• Tap-touch, three-speed capacitive control features a smooth, easy-to-clean surface.
• Dishwasher-safe deluxe filters feature quick-release latch for easy removal.
• CRT provides the ability to meet codes and reduce airflow to 300 CFM.
• 10 minute delay-off function keeps hood running after cooking to ensure smoke and odors have cleared the environment.
• O ptional non-duct recirculation kit and filters available.
• Ducted/non-ducted telescopic flue extension accommodates 8' to 9' ceiling heights. Flue extensions available to accommodate ceiling heights from 9' to 10'.
• Installation brackets are included for easy installation.








EW4330SS EW4336SS EW4336BLS
Elegant, clean lines form to create a sophisticated contemporary design that’s perfect for today’s modern kitchens. Quiet operation and bright LED lighting enhances your cooking experience, while the sleek 3-speed capacitive touch control makes operation and clean-up easy.
• Quiet 460 MAX Blower CFM operates at a best-in-class 1.5 sones at normal speed.
• Bright 2-level LED module (included).
• Tap-touch, three-speed capacitive control features a smooth, easy-to-clean surface.
• Dishwasher-safe deluxe filters feature quick-release latch for easy removal.
• CRT provides the ability to meet codes and reduce airflow to 300 CFM.
• 10 minute delay-off function keeps hood running after cooking to ensure smoke and odors have cleared the environment.
• O ptional non-duct recirculation kit and filters available.
• Ducted/non-ducted telescopic flue extension accommodates 8' to 9' ceiling heights. Flue extensions available to accommodate ceiling heights from 9' to 10'.
• Installation brackets are included for easy installation.


* M AX Blower CFM indicates hood blower performance in open air. Find HVI rated performance for this model in the product specification sheet at Broan-NuTone.com
† Sones at normal (or working) speed.
Install the hood so that the bottom of the unit is 24" to 30" above the cooking surface. Mounting height may be affected by ceiling height.




This hood offers traditional design with modern features. Bright LED lighting enhances your cooking experience, while the 3-speed back-lit soft touch control makes operation easy.
• Choose a powerful 450 CFM or 630 CFM blower to match cooking surface output, or cooking style needs.
• 450 MAX Blower CFM operates at a quiet 3 sones at normal speed.
• 6 30 MAX Blower CFM operates at a quiet 1.5 sones at normal speed (BWP2306SS and BWP2366SS models only).
• Bright 1-level LED modules (included) enhance your cooking experience.
• 3 -speed back-lit soft touch control for easy operation.
• Dishwasher-safe hybrid baffle filters feature quick-release latch for easy removal.
• 5 minute delay-off function keeps hood running after cooking to ensure smoke and odors have cleared the environment.
• O ptional non-duct recirculation kit and filters are available for indoor exhaust recirculation to suit your needs.
• Ducted/non-ducted telescopic flue extension accommodates 8' to 9' ceiling heights. Flue extensions are available to accommodate ceiling heights from 9' to 10'.



Backlit mode when active.







This sleek low-profile design is the perfect statement for today’s kitchens. Bright LED lighting enhances your cooking experience, while the 3-speed back-lit soft touch control makes operation easy.
• Powerful 450 MAX Blower CFM operates at a quiet 3 sones at normal speed.
• Bright 1-level LED modules (included) enhance your cooking experience.
• 3 -speed back-lit soft touch control for easy operation.
• Dishwasher-safe hybrid baffle filters feature quick-release latch for easy removal.
• 5 minute delay-off function keeps hood running after cooking to ensure smoke and odors have cleared the environment.
• O ptional non-duct recirculation kit and filters are available for indoor exhaust recirculation to suit your needs.
• Ducted/non-ducted telescopic flue extension accommodates 8' to 9' ceiling heights. Flue extensions are available to accommodate ceiling heights from 9' to 10'.






Clean lines form to create a slim contemporary design that’s perfect for today’s modern kitchens. Bright LED lighting enhances your cooking experience, while the 3-speed back-lit soft touch control makes operation easy.
• Powerful 450 MAX Blower CFM operates at a quiet 3 sones at normal speed.
• Bright 1-level LED modules (included) enhance your cooking experience.
• 3 -speed back-lit soft touch control for easy operation.
• Dishwasher-safe hybrid baffle filters feature quick-release latch for easy removal.
• 5 minute delay-off function keeps hood running after cooking to ensure smoke and odors have cleared the environment.
• O ptional non-duct recirculation kit and filters are available for indoor exhaust recirculation to suit your needs.
• Ducted/non-ducted telescopic flue extension accommodates 8' to 9' ceiling heights. Flue extensions are available to accommodate ceiling heights from 9' to 10'.






Clean lines form to create a slim contemporary design surrounded by black glass that’s perfect for today’s modern kitchens. Bright LED lighting enhances your cooking experience, while the sleek 3-speed capacitive touch control makes operation and clean up easy.
• Powerful 450 MAX Blower CFM operates at a quiet 3 sones at normal speed.
• Bright 1-level LED modules (included) enhance your cooking experience.
• 3 -speed capacitive touch control features a smooth, easy-to-clean surface.
• Dishwasher-safe hybrid baffle filters feature quick release latch for easy removal.
• 5 minute delay-off function keeps hood running after cooking to ensure smoke and odors have cleared the environment.
• O ptional non-duct recirculation kit and filters are available for indoor exhaust recirculation to suit your needs.
• Ducted/non-ducted telescopic flue extension accommodates 8' to 9' ceiling heights. Flue extensions are available to accommodate ceiling heights from 9' to 10'.






Featuring a traditional design, this chimney hood offers bright LED lighting that illuminates the cooktop.
• 3 80 MAX Blower CFM operates at a quiet 1.5 sones at normal speed.
• Bright 1-level LED modules (included) enhance your cooking experience.
• 3 -speed push button controls make operation easy.
• Dishwasher-safe aluminum mesh filters feature quick-release latch for easy removal.
• O ptional non-duct recirculation kit and filters are available for indoor exhaust recirculation to suit your needs.
• Ducted/non-ducted telescopic flue extension accommodates 8' to 9' ceiling heights. Flue extensions are available to accommodate ceiling heights from 9' to 10'.


*
AX Blower CFM indicates hood blower performance in open air. Find HVI rated performance for this model in the product specification sheet at Broan-NuTone.com
Sones at normal (or working) speed.
Install the hood so that the bottom of the unit is 30" above the cooking surface. Mounting height may be affected by ceiling height.




A sleek, low-profile design enhanced by a dazzling new finish. Create a signature look and focal point in any kitchen with this stunning black stainless chimney hood.
• Compact chimney with contemporary flair.
• Black stainless steel finish.
• Two widths 30" & 36"; in a 20" depth.
• Powerful internal 600 MAX Blower CFM operates at 1.5 sones at normal speed.
• Bright dual halogen lighting; 2-intensity settings (lamps included).
• Tap-touch, three-speed capacitive control features a smooth, easy-to-clean surface.
• Dishwasher-safe micro-mesh filters provide highly efficient grease removal. The electronic filter clean reminder ensures they will always maintain peak efficiency.
• O ptional non-duct recirculation kit available.
• Install hood so that the bottom of the unit is 24" to 30" above the cooking surface. Mounting height may be affected by ceiling height.
• Ducted telescopic flue accommodates ceiling heights from 8' to 9'. Flue extension for higher ceilings is also available.1






Inspiring traditional European design. This wonderful design is executed to meet todays needs so that everyone can achieve their dream.
• Traditional Italian design with high-performance features.
• Available in brushed stainless steel.
• Two widths 30" & 36"; in a 19-3/4" depth.
• Powerful internal 520 MAX Blower CFM.
• Bright dual halogen lighting; 3-intensity settings (35-watt lamps included).
• 3 -Speed electronic push button control with blue speed selection indication.
• Control features include Delay-off and Filter clean reminder.
• O ptional Remote Control Operation—BCR1.
• Quick release aluminum mesh filters.
• Designed to work with Broan Automatic Make-up air dampers.
• Heat Sentry™ detects excessive heat and adjusts blower speed automatically.
• Telescopic flue accommodates ceiling heights 8' to 9'. Flue extensions for higher ceilings are also available.1
SPECIFICATIONS

* M AX Blower CFM indicates hood blower performance in open air. Find HVI rated performance for this model in the product specification sheet at Broan-NuTone.com
† Sones at normal (or working) speed.




Elegant European curved glass design that is both beautiful and functional. The airy design is a stunning focal point that complements its surrounding perfectly.
• Contemporary Italian Glass Canopy design.
• Available in brushed stainless steel.
• Two widths 30" & 35-1/4"; in a 19-3/4" depth.
• Powerful internal 650 MAX Blower CFM.
• Bright dual halogen lighting; 3-intensity settings (35-watt lamps included).
• 3 -Speed electronic push button control with blue speed selection indication.
• Control features include Delay-off and Filter clean reminder.
• O ptional Remote Control Operation—BCR1.
• Quick release aluminum mesh filters.
• Designed to work with Broan Automatic Make-up air dampers.
• Heat Sentry™ detects excessive heat and adjusts blower speed automatically.
• Telescopic flue accommodates ceiling heights 8' to 9'. Flue extensions for higher ceilings are also available.1

1 Optional flue extension for either ducted or non-ducted 10' ceilings.
** Includes non-ducted filter & flex duct.
+ 299 CFM max with ARP6 reducer plate option.
* M AX Blower CFM indicates hood blower performance in open air. Find HVI rated performance for this model in the product specification sheet at Broan-NuTone.com
† Sones at normal (or working) speed.




Elegant symmetry from every angle. Graceful curves and a low-profile design make this island hood at home in any décor.
• Brushed stainless steel finish.
• 35-7/16" x 27-9/16" dimension.
• Multi-speed slide control.
• Four 20-watt halogen lamps included (one level).
• Dishwasher-safe aluminum filters.
• Telescopic flue accommodates 8' to 9' ceilings—flue extension available for 10' ducted and non-ducted applications.*
• Internal blower delivers 550 CFM (<300 CFM with ARP6 ).
• Non-ducted kit for indoor recirculation (purchase separately).
• Heat Sentry™ detects excessive heat and adjusts blower speed to high automatically.
SPECIFICATIONS
OPTIONAL ACCESSORIES
1 Includes non-ducted filter.
** 299 CFM max with ARP6 reducer plate option.
* M AX Blower CFM indicates hood blower performance in open air. Find HVI rated performance for this model in the product specification sheet at Broan-NuTone.com
† Sones at normal (or working) speed.




Beautiful contemporary European glass island design. The curved glass canopy provides a stunning focal point without blocking the view of your surroundings.
• Contemporary Italian Glass Canopy design.
• Available in brushed stainless steel.
• 35-3/8" x 25-5/8" dimension.
• Powerful internal 520 MAX Blower CFM.
• Bright quad halogen lighting; 3-intensity settings (lamps included).
• 3 -Speed electronic push button control with blue speed selection indication.
• Control features include Delay-off and Filter clean reminder.
• O ptional Remote Control Operation—BCR1.
• Quick release aluminum mesh filters.
• Designed to work with Broan Automatic Make-up air dampers.
• Heat Sentry™ detects excessive heat and adjusts blower speed automatically.


• Telescopic flue accommodates ceiling heights 8' to 9'. SPECIFICATIONS OPTIONAL ACCESSORIES
1 Optional flue extension for either ducted or non-ducted 9' to 10' ceilings.
† Sones at normal (or working) speed.
** Includes non-ducted filter & flex duct.
* M AX Blower CFM indicates hood blower performance in open air. Find HVI rated performance for this model in the product specification sheet at Broan-NuTone.com Optional BCR1 Remote Control Controls


• Brushed stainless steel finish.
• Bright halogen lighting; Two 50-watt bulbs in 30" and 36" widths, Three 50-watt bulbs in 42" and 48" widths (purchase bulbs separately).
• Pro-style, dishwasher-safe baffle filters with removable grease drip rail.
• Designed to duct out of the hood shell in either horizontal or vertical direction with internal blowers. External blowers duct vertically.
• Designed to work with Broan Automatic Make-Up Air Damper.




• Variable speed control remembers last setting—blue LED power-on indicator light.
• W hen venting to the exterior is not possible, an optional non-duct kit will filter air through charcoal filters and recirculate it back into the kitchen. E64000
• Heat Sentry™ detects excessive heat and adjusts blower speed automatically.

INTERNAL BLOWER SPECIFICATIONS (See page 74 for External blowers)
1 Duct adapter & damper is included with the Internal blowers.
◆ 120V 60Hz
* M AX Blower CFM indicates hood blower performance in open air. Find HVI rated performance for this model in the product specification sheet at Broan-NuTone.com
† Sones at normal (or working) speed.
EXTERNAL BLOWER SPECIFICATIONS
1 See pages 74–75 for Exterior (660–1620 MAX Blower CFM) and Inline (320–1540 MAX Blower CFM) blower specifications.
2 Sone levels are typically half of comparable CFM internal blowers.
3 External blower capable models include the 332KR rough-in kit, purchase blowers separately.
◆ 120V 60Hz
* M AX Blower CFM indicates hood blower performance in open air. Find HVI rated performance for this model in the product specification sheet at Broan-NuTone.com

Pro-style, dishwasher-safe baffle filters with removable grease drip rail. Filters feature handles for convenient removal.
Adapt to any installation.

Shown with non-duct recirculating kit.
Quality Broan Elite options let you create a custom look.

A non-duct kit may be used to recirculate filtered air back into the kitchen if ducting is not practical.
E64000 OPTIONS SELECTION TABLE

Restaurant-quality stainless steel backsplash with fold-down shelves completes the commercial look and is easy to clean.
† For models with internal blowers only.
* Includes non-ducted filters.
** Requires two packs for dual blower models.


• Brushed stainless steel finish.
• Bright halogen lighting; Two 50-watt bulbs in 30" and 36" widths, Three 50-watt bulbs in 42" and 48" widths (purchase bulbs separately).
• Pro-style, dishwasher-safe baffle filters with removable grease drip rail.
• Variable speed control remembers last setting—blue LED power-on indicator light.
• Heat Sentry™ detects excessive heat and adjusts blower speed automatically.
• Designed to duct out of the hood shell in either horizontal or vertical direction with any blower configuration.

• Designed to work with Broan Automatic Make-Up Air Damper.

• W hen venting to the exterior is not possible, an optional non-duct kit will filter air through charcoal filters and recirculate it back into the kitchen.



INTERNAL BLOWER SPECIFICATIONS (See page 74 for External blowers)
1 Duct adapter & damper is included with the Internal blowers.
◆ 120V 60Hz
* M AX Blower CFM indicates hood blower performance in open air. Find HVI rated performance for this model in the product specification sheet at Broan-NuTone.com
† Sones at normal (or working) speed.
EXTERNAL BLOWER SPECIFICATIONS
1 S ee pages 74–75 for Exterior (660–1620 MAX Blower CFM) and Inline (320–1540 MAX Blower CFM) blower specifications.
2 Sone levels are typically half of comparable CFM internal blowers.
3 External blower capable models include the 332KR rough-in kit, purchase blowers separately.
◆ 120V 60Hz
* M AX Blower CFM indicates hood blower performance in open air. Find HVI rated performance for this model in the product specification sheet at Broan-NuTone.com

Pro-style, dishwasher-safe baffle filters with removable grease drip rail. Filters feature handles for convenient removal.

Shown with non-duct recirculating kit.
Adapt to any installation to a create a custom look.


A non-duct kit may be used to recirculate filtered air back into the kitchen if ducting is not practical.
E60000 OPTIONS SELECTION TABLE


Restaurant-quality stainless steel backsplash with fold-down shelves completes the commercial look and is easy to clean.
† For models with internal blowers only.
* Includes non-ducted filters.
** Requires two packs for 1200 CFM Blower.


• Professional outdoor design.
• Deep 27" depth to handle heat and size of outdoor gas grills (optional 3" wall extension).
• Br ushed corrosion resistant stainless steel.
• Four widths: 36", 42", 48" and 60".
• Powerful 1290 MAX Blower CFM.
• Bright halogen lighting; two in 36" and 42", three in 48" and 60" models (bulbs not included).
• Three-speed rotary control designed to resist the effects of heat and moisture.
• Stainless steel baffle filters.
• Heat Sentry™ detects excessive heat and adjusts blower speed automatically.
• HVI certified performance.


EPD6148SS
EPD6160SS


Flue covers are available in corrosion resistant stainless steel and attach to the top of the range hood shell. Flue covers come in 6", 18" and 30" heights. Deeper flue covers are available for hoods using the 3" wall extension.


Optional


There when needed—hidden when not. Enjoy powerful ventilation at the touch of a button. Add a downdraft to an island installation—raise it when cooking, lower it when entertaining. Hide a power pack insert in custom cabinetry for a completely hidden solution. You have a vision. Broan will help you see it through.




This three-speed power pack insert delivers up to 440 CFM. The quick-release filter is dishwasher safe, and smooth surfaces clean easily. Achieve a custom look and protect cabinetry with stainless steel liners.
• 4 40 MAX Blower CFM, 2.5 sones at normal speed.
• Three-speed, push-button control includes a dedicated on/off.
• Bright LED strip-lighting modules illuminate evenly and are tested in cooking environments to ensure long life without dimming.
• Heat Sentry™ detects excessive heat and adjusts blower speed to high automatically.
• 6" round duct adapter with damper.
• Easy-to-clean, fully enclosed bottom with dishwasher-safe, aluminum-mesh filter.
• O ptional non-duct operation using 360NDK non-duct kit and charcoal filter, sold separately.
• Works with optional Universal Make-up Air Dampers.
• Works with optional stainless LB liners and painted LT liners.






This dual-speed power pack insert delivers 300 MAX Blower CFM in a compact size. Smooth surfaces clean easily, and quickrelease filters are dishwasher safe. Get a custom appearance while protecting cabinetry with stainless steel liners.
• 3 00 MAX Blower CFM, 8.0 sones at high speed.
• Two-speed rocker controls.
• Bright LED strip-lighting modules illuminate evenly and are tested in cooking environments to ensure long life without dimming.
• 7" round duct adapter.
• Easy-to-clean, fully enclosed bottom with dishwasher-safe, aluminum-mesh filter.
• O ptional non-duct operation using 358NDK non-duct kit and charcoal filter, sold separately.
• Works with optional Universal Make-up Air Dampers.
• Works with optional stainless LB liners and painted LT liners.





Power Pack Inserts and Modules are completely concealed in custom cabinetry.

High-performance ventilation solutions. These power pack inserts provide the ventilation and lighting you need for your custom application.
• Silver paint finish.
• Three speed, slide control.
• Heat Sentry™ detects excessive heat and adjusts speed automatically.
• Quiet centrifugal blower, 440 MAX Blower CFM (vertical discharge) (<300 CFM with ARP6).
• Dual 40-watt lamps (purchase separately).
• Dishwasher safe aluminum filter.
• For ducted installations, includes adapter and damper for 6" round duct.
• O ptional non-ducted filter kit (purchase 357NDK separately).
• Works with optional custom hood liners in 30", 36", “Box” or “T” design.
• ENERGY STAR® version on page 43.
• Silver paint finish.
• Two speed motor, rocker control.
• Efficient 300 MAX Blower CFM fan (vertical discharge).
• Dual 40-watt lighting (purchase lamps separately).

• Dishwasher safe aluminum filter.
• For ducted installations, built-in adapter for 7" round duct.
• O ptional non-ducted filter kit (purchase 356NDK separately).
• Works with optional custom hood liners in 30", 36", “Box” or “T” design.
SPECIFICATIONS
OPTIONAL ACCESSORIES
† Includes charcoal filter. Some duct work is required for non-ducted applications.
* 299 CFM max with ARP310 reducer plate option.
** M AX Blower CFM indicates hood blower performance in open air. Find HVI rated performance for this model in the product specification sheet at Broan-NuTone.com


Broan “T” and “B” liners provide an elegant way to finish a traditional wood hood and protect cabinetry. They feature a durable silver painted finish and a 4" depth for good capture. Hemmed edges hide exposed edges, and pre-drilled mounting holes make installation easy.




Depending on your installation of the non-duct system, you may need additional duct or duct components (e.g., elbows).




Slides out of sight when not in use. This slimline design merges perfectly with the style of any kitchen. The unseen advantages include quiet, powerful ventilation performance.
• Compact, trim styling complements any kitchen.
• Fan and light automatically turn on when you slide out the clear glass visor; shut off when pushed in.
• Energy-efficient, 24" fluorescent light with prismatic glass lens provides bright, even cooktop lighting (bulb not included).
• Dual centrifugal blower, 490 MAX Blower CFM at a quiet 4.5 sones at high speed.
• Infinitely adjustable blower control conveniently located up front; features blower memory—when activated, unit automatically “remembers” the last setting you selected.
• Heat Sentry™ detects excessive heat and adjusts blower speed to high automatically.
• Includes 3-1/4" x 10" duct adapter with built-in damper.


SPECIFICATIONS
* Bulb not included.
† 299 CFM max with ARP310 reducer plate option.
** M AX Blower CFM indicates hood blower performance in open air. Find HVI rated performance for this model in the product specification sheet at Broan-NuTone.com




The PM500SS delivers the features you expect and the power you need. Serious cooks will appreciate the full surface coverage of the halogen lighting. Smooth surfaces and quickrelease filters clean easily.
• 550 MAX Blower CFM, 9.0 sones at high speed.
• Three-speed, push-button control includes a dedicated on/off.
• Dual halogen bulbs with single light level for bright cooktop lighting (Type JC, 12V, 20W, G4 base), included.
• 6" round duct.
• Easy-to-clean, fully enclosed bottom with dishwasher-safe, aluminum-mesh filters.
• O ptional non-duct operation using 359NDK non-duct kit and charcoal filter, sold separately.
• Works with optional Universal Make-up Air Dampers.
• Works with optional LT and LB liners.




The Broan Elite RMIP Pro-Style Power Pack Insert fits flush with the bottom of the cabinet or custom hoods. Centrifugal blower options from 530 to 1650 MAX Blower CFM with multi-speed control provide quiet and effective performance. Halogen lighting complements the beauty of its fully-enclosed, easy-to-clean bottom.
• Brushed stainless steel finish.
• Design allows use with custom liners or Broan Elite Pro-Style Insert liners (sold separately).
• Pro-Style Insert available in 33" and 45" widths.
• Variable speed control for quiet operation.
• O ptional remote wall control available.
• Heat Sentry™ detects excessive heat and adjusts blower speed to high automatically.
• Dishwasher-safe stainless steel/ aluminum filters, or optional baffle filters.
• Bright halogen lighting, two 50-watt lamps (RMIP33) or three 50-watt lamps (RMIP45), bulbs not included.
• Choose 530 or 930 MAX Blower CFM Internal, or choice of eight External blower options: four Exterior: 660, 880, 1280, or 1620 MAX Blower CFM, or four In-Line: 320 ,670, 890 or 1540 MAX Blower CFM. All blowers sold separately.


45-3/4"
RMIP45
• O ptional liners in 36", 42", 48" and 60" widths protect custom hoods.

*
* All blowers must be purchased separately and are HVI Certified.
See blower specifications table on pages 74–75.
▲ All ratings for vertical duct only.
** M AX Blower CFM indicates hood blower performance in open air. Find HVI rated performance for this model in the product specification sheet at Broan-NuTone.com
† Sones at normal (or working) speed. 323/8"(RMIP33),443/8"(RMIP45)
Broan Elite Liners provide a beautiful way to finish your custom hood and protect your cabinetry. Designed to work with Broan Elite Pro-Style Power Pack Insert and Power Pack Inserts, liners feature a 3" adjustable nose to provide application flexibility, and a 4" depth for excellent capture.
• Brushed stainless steel finish.
• Liners are available for 36", 42", 48" and 60" widths.
• Liners allow depth adjustment from 22-1/2" to 25-1/2". Fits stock 24" cabinets.
• Liners are based on the outside width of the custom hood.
• All models compliant with CA Title 24.
1. Select the right size Pro-Style Insert
• RMIP33 (33" width) or RMIP45 (45" width)
• Both feature an 18-7/16" depth
• 530 or 930 MAX Blower CFM
Internal blower options
• 320–1500 MAX Blower CFM
External blower options
2. Select a Liner to fit your Cabinetry
For cabinet/hood inside depths of 23"–26" choose:
• RML3336S 36" width, use with RMIP33
• RML3342S 42" width, use with RMIP33
• RML4548S 48" width, use with RMIP45
• RML4560S 60" width, use with RMIP45
3. Select a blower for your Insert
Internal blowers:
• P5 (530 MAX Blower CFM)
• P8 (930 MAX Blower CFM)
Exterior blowers (outside, roof or wall):
• 331H (660 MAX Blower CFM)*
• 332H (880 MAX Blower CFM)*
• 335 (1280 MAX Blower CFM)*
• 336 (1620 MAX Blower CFM)* In-Line blowers (inside, attic or other space):
• HLB3 (320 MAX Blower CFM)
• HLB6 (670 MAX Blower CFM)*
• HLB9 (890 MAX Blower CFM)*
• HLB11 (1540 MAX Blower CFM)*

* 332KR Rough-In Kit is required when used with Exterior and In-Line blower options above (purchased separately).
RML3336S/RML3342S For RMIP33
RML4548S/RML4560S For RMIP45



The Broan Elite Custom Power Pack Insert is designed to fit flush with the bottom of a cabinet or custom hood that’s 30" to 48" wide. The 400 CFM centrifugal blower is combined with a multi-speed control to provide quiet, effective performance. Halogen lighting complements the beauty of a fully enclosed bottom containing dishwasher-safe filters.
• Three-speed control.
• Heat Sentry™ detects excessive heat and adjusts blower speed to high automatically.
• Internal 550 MAX Blower CFM (<300 CFM with ARP6).
• E xternal blower model (RMPE) allows a choice of eight blower options: four Exterior: 600, 900, 1200 or 1500 CFM, or four In-Line: 280, 600, 800 or 1100 CFM.
• Two 50-watt halogen lamps included (one level).
• Dishwasher-safe aluminum filters feature a quick-release latch and professional-style appearance.
• O ptional non-ducted filters (FILTEREB40) for indoor exhaust recirculation, some ductwork required (RMP17004 only).

• Install power pack so that the bottom of the unit is 24" to 30" above the cooking surface.

EXTERNAL BLOWER 27-9/6" RMPE7004
• O ptional custom hood liners in 30", 36" and 48" widths.
†
blowers sold separately.
* All blowers are HVI Certified.
Some ductwork required for RMP1 non-ducted installations.
+ 299 CFM max with ARP6 reducer plate option.
* M AX Blower CFM indicates hood blower performance in open air. Find HVI rated performance for this model in the product specification sheet at Broan-NuTone.com


Broan Elite Liners provide a beautiful way to finish your custom hood and protect your cabinetry. Designed to work with Broan Elite Pro-Insert and Power Packs, liners feature a 3" adjustable nose to provide application flexibility, and a 4” depth for excellent capture.
• Brushed stainless steel finish.
• Liners protect custom hoods and are available for 30", 36" and 48" widths.
• Two versions for maximum flexibility in depth adjustment:
“S” version adjusts 17-1/8"–20-1/8".
“L” version adjusts 20-1/8"–23-1/8".
• Liners are based on the outside width of the custom hood.
1. Select a Power Pack system
RMP17004, 400 CFM Internal blower
• 27-9/16" width, 11-1⁄4" depth
RMPE7004, 320–1620 MAX Blower CFM External blower options
• 27-9⁄16" width, 11-1⁄4" depth
2. Select a Liner to fit your Cabinetry
If the cabinet/hood inside depth is 18"–21", choose model:
• RML7030S for 30" width
• RML7036S for 36" width
• RML7048S for 48" width
If the cabinet/hood inside depth is 21"–24", choose model:
• RML7030L for 30" width
• RML7036L for 36" width
• RML7048L for 48" width

3. Select an Internal or External Blower
RMP17004, Internal 400 CFM blower is included
RMPE7004, External blower options (choose one): Exterior blowers (outside, roof or wall):
• 331H (660 MAX Blower CFM)*
• 332H (880 MAX Blower CFM)*
• 335 (1280 MAX Blower CFM)*
• 336 (1620 MAX Blower CFM)*
In-Line blowers (inside, attic or other space):
• HLB3 (320 MAX Blower CFM)
• HLB6 (670 MAX Blower CFM)*
• HLB9 (890 MAX Blower CFM)*
• HLB11 (1540 MAX Blower CFM)*
* 8"–10" transition (model 414) is required for the Exterior or In-Line models.
RML7030S/RML7030L
RML7036S/RML7036L
RML7048S/RML7048L
For RMP17004 and RMPE7004 Packs






Ready where and when you need it. Rises to new heights to meet the needs of high-end commercial style cooking.
• Compact design is installed directly behind the cooktop for an unobtrusive appearance. Thin profile saves precious space under the cabinet.
• Chimney rises over 9-1/2" when activated, ideal for large pots and pans.
• Infinitely adjustable control is designed to provide convenient access to govern the blower speed for effective and quiet operation.
• O ptional remote control will activate downdraft from an alternate location.
• Heat Sentry™ detects excessive heat and adjusts blower speed to high automatically.

• Dishwasher-safe filters are easy to remove and feature a stylish brushed stainless steel appearance for a professional look.
• These units are not for installations behind ovens.
• 6 00 MAX Blower CFM centrifugal blower or choice of eight External blower options: four Exterior blowers from 660 to 1540 MAX Blower CFM, or four In-Line blowers from 660 to 1620 MAX Blower CFM. See pages 74–75.
• Unique ducting capability allows the internal or remote blower connection to be ducted to the left, right or downward.
† External and In-Line blowers sold separately.

* M AX Blower CFM indicates hood blower performance in open air. Find HVI rated performance for this model in the product specification sheet at Broan-NuTone.com
** 299 CFM max with ARP310 reducer plate option.
Install the hood so that the bottom of the unit is 24" to 30" above the cooking surface. Mounting height may be affected by ceiling height.



273023C 273003 273603 EXTERNAL 30" 283003

Convenient options help assure a custom fit. For the unique demands of cooktops in islands and peninsulas.
• Innovative downdraft system is compatible with virtually all selfcontained cooktops.
• Sleek, trim styling complements any cooktop style or color.
• Automatically rises 7" with the touch of a button. Disappears flush with cooktop surface.
• Space-saving design lets you make the most of precious, under-counter cabinet space.
• Infinitely adjustable speed control is flush with the side of the unit; inconspicuous, yet easy to reach and simple to use.
• Model 27000 Blower discharges right, left or down and slides side-to-side to ease installation.
• These units are not for installations behind ovens.
• Stainless Steel cover standard. White or Black optional.
SPECIFICATIONS
1 M AX Blower CFM indicates hood blower performance in open air. Find HVI rated performance for this model in the product specification sheet at Broan-NuTone.com
+ 299 CFM max with ARP310 reducer plate option.
* E xternal unit utilizes model 332H Exterior-mounted blower. InLine blower sold separately.
** Cooktops, countertops and cabinets vary in dimension and support systems depending upon manufacturer. These factors may impact the ability to fit with every worktop/cabinet combination. Specifications subject to change without notice.
† M odel 28000 requires transitioning from 3-1/4" x 10" to 10" round for connection to the External blower.
Model 28000
Use with 880 MAX Blower CFM Exterior blower (Model 332H) or In-Line blower.
Model 27000
Includes 600 MAX Blower CFM Internal blower (<300 CFM with ARP310).

Shown: BCSEK130BL on page 46
Broan makes it easy to go green with a variety of ENERGY STAR® certified range hoods. With efficient motor designs as well as LED and compact fluorescent lighting options, these range hoods meet the program requirements of USGBC,® LEED® and NAHB.





ENERGY STAR® efficiency, for custom applications provides the ventilation and lighting you need in one integrated package.
• Silver paint finish.
• Three speed, slide control.
• Heat Sentry™ detects excessive heat and adjusts speed automatically.
• Quiet centrifugal blower, 350 MAX Blower CFM (vertical discharge).
• 0.5 Sones at normal speed (130 CFM).
• Dual 13-watt fluorescent lamps included.
• Dishwasher safe aluminum filter.
• For ducted installations, includes adapter and damper for 6” round duct.
• Works with optional custom hood liners in 30", 36", “Box” or “T” design.
SPECIFICATIONS OPTIONAL ACCESSORIES
* M AX Blower CFM indicates hood blower performance in open air. Find HVI rated performance for this model in the product specification sheet at Broan-NuTone.com † Sones at normal (or working) speed.





Broan Elite brings you Spire, an exciting new shape in a pro-style hood. Its high efficiency ensures energy savings while you enjoy pro-style performance.
• The Captur™ system’s advanced blower design features a forward positioned centric inlet to remove smoke and odor faster. Three-speed blower control exhausts at a powerful 650 MAX Blower CFM.
• Forward placement and smooth-flow blower wheel design ensure quiet, <0.3 sone operation at normal speed.
• Bright, two-level LED modules— supported by a 3-year warranty— illuminate evenly and are tested in cooking environments to ensure long life without dimming. ENERGY STAR® qualified LEDs maximize savings.
• Tap-touch, 3-speed capacitive control features a smooth, easy-to-clean surface.
• Dishwasher-safe, hybrid baffle filters provide ultra-efficient grease removal with superior air flow. The filter clean reminder ensures they will always maintain a high level of capture.
• E Z1 brackets enable single-person installation in less than half the time of traditional methods.
• ADA compliant, remote operation is possible using a standard UL approved wall switch (kit sold separately).
• Non-duct capable with use of charcoal filters, sold separately. Hidden louvers on top of hood exhaust away from cabinetry.
• Non-duct installation does not meet ENERGY STAR® requirements.
* Kit sold separately.
† Sones at normal (or working) speed.









The slim and refined lines of Sahale bring a refreshing change to today’s kitchens. Bright ENERGY STAR® certified LED lighting complements your cooking experience and three fan speeds make cooking more enjoyable.
• The Captur™ system’s advanced blower design features a forward positioned centric inlet to remove smoke and odor faster. A smooth-flow blower wheel and high flow filters ensure quiet operation.
• 375 MAX Blower CFM operates at 1.5 sones at normal speed; as low as 1.2 sones in some duct configurations
• Bright, two-level LED modules— supported by a 3-year warranty— illuminate evenly and are tested in cooking environments to ensure long life without dimming. ENERGY STAR® certification saves energy expense.
• Tap-touch, three-speed capacitive control features a smooth, easy-to-clean surface.
• Dishwasher-safe, deluxe micro-mesh filters provide highly efficient grease removal and patterned cover provides a decorative design. The filter clean reminder ensures a high level of capture.
• E Z1 brackets make it easy for singleperson installation in less than half the time of traditional methods.
• ADA compliant, remote operation is possible using a standard UL approved wall switch. Requires ADA Adapter Kit.
• Non-duct capable with use of charcoal filters, sold separately. Hidden louvers on top of hood exhaust away from cabinetry.
• Non-duct installation does not meet ENERGY STAR® requirements.


* M AX Blower CFM indicates hood blower performance in open air. Find HVI rated performance for this model in the product specification sheet at Broan-NuTone.com
† Sones at normal (or working) speed. For faster smoke and odor removal.






• The Captur™ system’s advanced blower design features a forward positioned centric inlet to remove smoke and odor faster. A smooth-flow blower wheel and high flow filters ensure quiet operation.
• 3 00 MAX Blower CFM operates at 1.5 sones at normal speed.
• Bright, single intensity LED modules— supported by a 3-year warranty— illuminate evenly and are tested in cooking environments to ensure long life without dimming. ENERGY STAR® certification saves energy expense.
• Hidden two-speed on/off rocker switch.
• Dual dishwasher-safe, open-mesh filters provide efficient grease removal.
• E Z1 brackets make it easy for singleperson installation in less than half the time of traditional methods.
• ADA compliant, remote operation is possible using a standard UL approved wall switch.
• Non-duct capable with use of charcoal filters, sold separately. Hidden louvers on top of hood exhaust away from cabinetry.
• Non-duct installation does not meet ENERGY STAR® requirements.


® The clean, contemporary shape of Glacier complements any kitchen design. Impressive ENERGY STAR® certified LED lighting and superior smoke and odor removal are a mere introduction to everything this hood has to offer.




Every kitchen needs adequate ventilation matched to your cooking style, and your unique sense of style. That’s why Broan redesigned nearly every hood in our popular under cabinet category. For style, LED lighting, control options and more—start here.





The sculpted lines of Alta® bring an exciting, new choice to typical range hood shapes. Sophisticated curves and perimeter aspiration enable new design possibilities while you experience the ultimate in capture efficiency.
• The Captur™ system’s advanced blower design features a forward positioned centric inlet to remove smoke and odor faster. Three-speed control operates a powerful blower with 650 MAX Blower CFM.
• Smooth-flow blower wheel design and high flow filters ensure quiet, <0.3 sone operation at normal speed.
• Bright, three-level LED modules— supported by a 3-year warranty— illuminate evenly and are tested in cooking environments to ensure long life without dimming.
• Three-speed, whisper touch infrared control is a pleasure to use and admire. Delay off feature runs the blower for 10 minutes after cooking to clear the air.
• Broan Heat Sentry™ detects excessive heat and adjusts the blower speed to prolong the life of the product and provide proper ventilation.
• Dishwasher-safe, open-mesh filters enhance grease removal behind a peripheral panel that increases capture of cooking effluents. The filter clean reminder ensures they will always maintain a high level of capture.
• E Z1 brackets make it easy for singleperson installation in less than half the time of traditional methods.
• ADA compliant, remote operation is possible using a standard UL approved wall switch (kit sold separately).
• Non-duct capable with use of charcoal filters, sold separately. Hidden louvers on top of hood exhaust away from cabinetry.
• O ptional HCR3 handheld remote enables control from anywhere in the kitchen.






The sculpted lines of Alta® bring an exciting, new choice to typical range hood shapes. Sophisticated curves, infrared controls and hybrid baffle filters lend a pro-style edge to your kitchen.
• The Captur™ system’s advanced blower design features a forward positioned centric inlet to remove smoke and odor faster. Three-speed blower control exhausts at a strong 450 MAX Blower CFM.
• Smooth-flow blower wheel design and high flow filters ensure quiet, <0.5 sone operation at normal speed.
• Bright, three-level LED modules— supported by a 3-year warranty— illuminate evenly and are tested in cooking environments to ensure long life without dimming.
• Three-speed, whisper touch infrared control is a pleasure to use and admire. Delay off feature runs the blower for 10 minutes after cooking to clear the air.
• Broan Heat Sentry™ detects excessive heat and adjusts the blower speed to prolong the life of the product and provide proper ventilation.
• Dishwasher-safe, hybrid baffle filters provide ultra-efficient grease removal with superior air flow. The filter clean reminder ensures they will always maintain a high level of capture.
• E Z1 brackets make it easy for singleperson installation in less than half the time of traditional methods.
• ADA compliant, remote operation is possible using a standard UL approved wall switch (kit sold separately).
• Non-duct capable with use of charcoal filters, sold separately. Hidden louvers on top of hood exhaust away from cabinetry.
• O ptional HCR3 handheld remote enables control from anywhere in the kitchen.

*









The sculpted lines of Alta® bring an exciting, new choice to typical range hood shapes. Wide curves and tap touch controls present a clean, striking design.
• The Captur™ system’s advanced blower design features a forward positioned centric inlet to remove smoke and odor faster. Three-speed blower control exhausts at 375 MAX Blower CFM.
• Smooth-flow blower wheel design and high flow filters ensure quiet, 1.5 sone operation at normal speed.
• Bright, two-level LED modules— supported by a 3-year warranty— illuminate evenly and are tested in cooking environments to ensure long life without dimming.
• Tap-touch, 3-speed capacitive control features a smooth, easy-to-clean surface.
• Dishwasher-safe, deluxe micro-mesh filters provide highly efficient grease removal and patterned cover provides a decorative complement to the hood design. The filter clean reminder ensures they will always maintain a high level of capture.
• E Z1 brackets make it easy for singleperson installation in less than half the time of traditional methods.
SPECIFICATIONS
• ADA compliant, remote operation is possible using a standard UL approved wall switch (kit sold separately).
• Non-duct capable with use of charcoal filters, sold separately. Hidden louvers on top of hood exhaust away from cabinetry.
OPTIONAL ACCESSORIES







The sculpted lines of Alta® bring an exciting, new option to typical range hood shapes. Brilliant halogen lighting and hidden controls offer a beautiful alternative to traditional designs.
• The Captur™ system’s advanced blower design features a forward positioned centric inlet to remove smoke and odor faster. Three-speed blower control exhausts at 300 MAX Blower CFM.
• Forward placement and smooth-flow blower wheel design ensure quiet, 1.5 sone operation at normal speed.
• Two-level, halogen bulbs illuminate the cooktop and counter area (bulbs included).
• Hidden on/off rocker switches control blower speeds and light levels.
• Dishwasher-safe, micro-mesh filters provide efficient grease removal.
• E Z1 brackets enable single-person installation in less than half the time of traditional methods.
• ADA compliant, remote operation is possible using a standard UL approved wall switch.
• Non-duct capable with use of charcoal filters, sold separately. Hidden louvers on top of hood exhaust away from cabinetry.
SPECIFICATIONS


OPTIONAL ACCESSORIES







Tenaya is a slim, transitional design with gentle radius features that make it perfect for today’s contemporary kitchens. This beautiful design includes features that make it a pleasure to use and easy to maintain.
• The Captur™ system’s advanced blower design features a forward positioned centric inlet to remove smoke and odor faster. Three-speed blower control exhausts at 375 MAX Blower CFM.
• Smooth-flow blower wheel design and high flow filters ensure quiet, 1.5 sone operation at normal speed.
• Bright, two-level LED modules— supported by a 3-year warranty— illuminate evenly and are tested in cooking environments to ensure long life without dimming.
• Tap-touch, 3-speed capacitive control features a smooth, easy-to-clean surface.
• Dishwasher-safe, micro-mesh filters provide efficient grease removal. The filter clean reminder ensures they will always maintain a high level of capture.
• E Z1 brackets make it easy for singleperson installation in less than half the time of traditional methods.
• ADA compliant, remote operation is possible using a standard UL approved wall switch (kit sold separately).


• Non-duct capable with use of charcoal filters, sold separately. Hidden louvers on top of hood exhaust away from cabinetry. SPECIFICATIONS OPTIONAL ACCESSORIES







Slim lines and graceful radiuses combine to make Tenaya the perfect companion to today’s contemporary kitchens. This beautiful design includes halogen lighting to light the cooktop and make cooking a pleasure.
• The Captur™ system’s advanced blower design features a forward positioned centric inlet to remove smoke and odor faster. Two-speed blower control exhausts at 300 MAX Blower CFM.
• Smooth-flow blower wheel design and high flow filters ensure quiet, 1.5 sone operation at normal speed.
• Two-level, halogen bulbs flood the cooktop and surrounding area with generous illumination. (50W bulbs sold separately)
• Hidden on/off rocker switches controls two blower speeds and light levels.
• L arge dishwasher-safe, single open-mesh filter provides efficient grease removal.
• ADA compliant, remote operation is possible using a standard UL approved wall switch.
• Non-duct capable with use of charcoal filters, sold separately. Hidden louvers on top of hood exhaust away from cabinetry.






BPDP136SS
BPDP142SS
BPDP148SS

Broan brings you Spire, an exciting new shape in a pro-style hood. The new design incorporates modern features like the quiet Captur™ system and LED lighting.
• The Captur™ system’s advanced blower design features a forward positioned centric inlet to remove smoke and odor faster. Two-speed blower control exhausts at a strong 450 MAX Blower CFM.
• Smooth-flow blower wheel design and high flow filters ensure quiet operation; as low as 0.4 sones in some duct configurations.
• Bright, single intensity LED modules—supported by a 3-year warranty—illuminate evenly and are tested in cooking environments to ensure long life without dimming.
• Streamlined, deluxe 2-speed rocker control operates light and fan speeds.
• Pro-style, dishwasher-safe, hybrid baffle filters provide ultra-efficient grease removal with superior air flow.
• E Z1 brackets make it easy for singleperson installation in less than half the time of traditional methods.
• ADA compliant, remote operation is possible using a standard UL approved wall switch.
• Non-duct capable with use of charcoal filters, sold separately. Hidden louvers on top of hood exhaust away from cabinetry.


For faster smoke and odor removal. SPECIFICATIONS OPTIONAL ACCESSORIES
* M AX Blower CFM indicates hood blower performance in open air. Find HVI rated performance for this model in the product specification sheet at Broan-NuTone.com
† Sones at normal (or working) speed.







The luxury of an LCD display and deluxe micro-mesh filters will make any meal preparation delightful. And, the Glacier range hood’s contemporary shape complements any kitchen design.
• The Captur™ system’s advanced blower design features a forward positioned centric inlet to remove smoke and odor faster. A smooth-flow blower wheel and high flow filters ensure quiet operation.
• A s trong 450 MAX Blower CFM operates as quietly as 0.4 sones at normal speed.
• Bright, three-level LED modules— supported by a 3-year warranty— illuminate evenly and are tested in cooking environments to ensure long life without dimming.
• Three-speed electronic pushbutton control incorporates an LCD display to show hood status for fan and light setting, filter clean reminder, Heat Sentry™ and delay off.
• Broan Heat Sentry™ detects excessive heat and adjusts the blower speed to prolong the life of the product and provide proper ventilation.
• Dishwasher-safe, deluxe micro-mesh filters provide highly efficient grease removal and patterned cover provides a decorative complement to the hood design. The filter clean reminder ensures they will always maintain a high level of efficiency.
• E Z1 brackets make it easy for singleperson installation in less than half the time of traditional methods.
• ADA compliant, remote operation.
• Non-duct capable with use of charcoal filters, sold separately. Hidden louvers on top of hood exhaust away from cabinetry.


* M AX Blower CFM indicates hood blower performance in open air. Find HVI rated performance for this model in the product specification sheet at Broan-NuTone.com † Sones at normal (or working) speed.







The clean, contemporary shape of Glacier complements any kitchen design. Impressive LED lighting and superior smoke and odor removal are a mere introduction to everything this hood has to offer.
• The Captur™ system’s advanced blower design features a forward positioned centric inlet to remove smoke and odor faster. A smooth-flow blower wheel and high flow filters ensure quiet operation.
• 375 MAX Blower CFM operates at 2.0 sones at normal speed; as low as 1.5 sones in some duct configurations.
• Bright, two-level LED modules— supported by a 3-year warranty— illuminate evenly and are tested in cooking environments to ensure long life without dimming.
• Tap-touch, three-speed capacitive control features a smooth, easy-to-clean surface.
• Dishwasher-safe, micro-mesh filters provide efficient grease removal. The filter clean reminder ensures they will always maintain a high level of capture.
• E Z1 brackets make it easy for singleperson installation in less than half the time of traditional methods.
• ADA compliant, remote operation.
• Non-duct capable with use of charcoal filters, sold separately. Hidden louvers on top of hood exhaust away from cabinetry.


SPECIFICATIONS OPTIONAL ACCESSORIES
* M AX Blower CFM indicates hood blower performance in open air. Find HVI rated performance for this model in the product specification sheet at Broan-NuTone.com † Sones at normal (or working) speed.





The clean, contemporary shape of Glacier complements any kitchen design. This new design has features like the quiet Captur™ system and brilliant halogen lighting. BCSD130BC
• The Captur™ system’s advanced blower design features a forward positioned centric inlet to remove smoke and odor faster. A smooth-flow blower wheel and high flow filters ensure quiet operation.
• 3 00 MAX Blower CFM operates at 1.5 sones at normal speed.
• Two-level, halogen bulbs flood the cooktop and surrounding area with generous illumination (50W bulbs not included).
• Hidden two-speed on/off rocker switch.

• Dual dishwasher-safe, open-mesh filters provide efficient grease removal.
• E Z1 brackets make it easy for singleperson installation in less than half the time of traditional methods.
• ADA compliant, remote operation is possible using a standard UL approved wall switch.

• Non-duct capable with use of charcoal filters, sold separately. Hidden louvers on top of hood exhaust away from cabinetry.


For faster smoke and odor removal.
HPF24 (Type Xb)
HPF30 (Type Xc)
HPF36 (Type Xd)
HPF42 (Type Xe)
* M AX Blower CFM indicates hood blower performance in open air. Find HVI rated performance for this model in the product specification sheet at Broan-NuTone.com
† Sones at normal (or working) speed.





The slim and refined lines of Sahale bring a refreshing change to today’s kitchens. Bright LED lighting complements your cooking experience and three fan speeds make cooking more enjoyable. BKDB130WW BKDB136WW BKDB136BL BKDB136SS
• The Captur™ system’s advanced blower design features a forward positioned centric inlet to remove smoke and odor faster. A smooth-flow blower wheel and high flow filters ensure quiet operation.
• 3 00 MAX Blower CFM operates at 1.5 sones at normal speed.
• Bright, two-level LED modules— supported by a 3-year warranty— illuminate evenly and are tested in cooking environments to ensure long life without dimming.
• Tap-touch, three-speed capacitive control features a smooth, easy-to-clean surface.
*

• Dishwasher-safe, micro-mesh filters provide efficient grease removal. The filter clean reminder ensures they will always maintain a high level of capture.
• E Z1 brackets make it easy for singleperson installation in less than half the time of traditional methods.
• ADA compliant, remote operation is possible using a standard UL approved wall switch. Requires ADA Adapter Kit.
• Non-duct capable with use of charcoal filters, sold separately. Hidden louvers on top of hood exhaust away from cabinetry.



Find HVI rated performance for this model in the product specification sheet at Broan-NuTone.com † Sones at normal (or working) speed.







The slim and refined lines of Sahale bring a refreshing change to today’s kitchens. Brilliant halogen lighting and a deluxe rocker control complements your cooking experience.
• The Captur™ system’s advanced blower design features a forward positioned centric inlet to remove smoke and odor faster. A smooth-flow blower wheel and high flow filters ensure quiet operation.
• 3 00 MAX Blower CFM operates at 1.5 sones at normal speed.
• Two-level, halogen bulbs flood the cooktop and surrounding area with generous illumination (bulbs included).
• Streamlined, deluxe rocker control operates two fan speeds.
• Dishwasher-safe, micro-mesh filters provide efficient grease removal.
• E Z1 brackets make it easy for singleperson installation in less than half the time of traditional methods.
• ADA compliant, remote operation is possible using a standard UL approved wall switch.
• Non-duct capable with use of charcoal filters, sold separately. Hidden louvers on top of hood exhaust away from cabinetry.
SPECIFICATIONS


OPTIONAL ACCESSORIES
* M AX Blower CFM indicates hood blower performance in open air. Find HVI rated performance for this model in the product specification sheet at Broan-NuTone.com
† Sones at normal (or working) speed.







The slim and refined lines of Sahale bring a refreshing change to today’s kitchens. Brilliant halogen lighting and hidden rocker controls complements your cooking experience.
• The Captur™ system’s advanced blower design features a forward positioned centric inlet to remove smoke and odor faster. A smooth-flow blower wheel and high flow filters ensure quiet operation.
• 3 00 MAX Blower CFM operates at 1.5 sones at normal speed.
• Two-level, halogen bulbs flood the cooktop and surrounding area with generous illumination (bulbs included)
• Hidden two-speed on/off rocker switch.
• L arge dishwasher-safe, single open-mesh filter provides efficient grease removal.
• ADA compliant, remote operation is possible using a standard UL approved wall switch.
• Non-duct capable with use of charcoal filter, sold separately. Hidden louvers on top of hood exhaust away from cabinetry.
SPECIFICATIONS


* M AX Blower CFM indicates hood blower performance in open air. Find HVI rated performance for this model in the product specification sheet at Broan-NuTone.com † Sones at normal (or working) speed.







With gentle round surfaces this transitional hood design is a great choice for contemporary kitchens. Hidden rocker switches conveniently control blower operation and bright LED lighting. A dishwasher-safe filter, integrated light panel and top side recirculation louvers clean easily.
• 270 MAX Blower CFM provides adequate capture and operates at 2.0 sones at normal speed.
• One-level LED lighting illuminates the cooking surface.
• 4 -way convertibility enables flexible installation in ducted or non-ducted applications.
• Hidden two-speed on/off rocker switch.
• L arge dishwasher safe, single aluminum mesh filter provides efficient grease removal.
• ADA compliant, remote operation is possible using a standard UL approved wall switch.
• Non-duct capable with use of charcoal filter, sold separately. Hidden louvers on top of hood exhaust away from cabinetry.
SPECIFICATIONS


OPTIONAL ACCESSORIES
* M AX Blower CFM indicates hood blower performance in open air. Find HVI rated performance for this model in the product specification sheet at Broan-NuTone.com
† Sones at normal (or working) speed.








Deluxe, variable-speed performance in an economical package. The infinitely adjustable speed control allows you to set the hood speed for the perfect combination of ventilation and quiet.
• 260 MAX Blower CFM (7" round), 2.5 sones at normal speed.
• Easily installs as 7" round vertical discharge; 3-1/4" x 10" vertical discharge; 3-1/4" x 10" horizontal discharge or non-ducted (non-ducted filter sold separately).
• Rotary, infinitely adjustable fan-speed control.
• Up to 75-watt cooktop lighting with protective polymeric lens and twolevel light control (bulb not included).
• Includes 3-1/4" x 10" damper/adapter and 7" round adapter.
• 7" round damper optional.
• BP87Q damper sold separately.
• ADA compliant, remote operation is possible using a standard UL approved wall switch.






Introducing our easy installation system to Broan’s economy range hood offering. Broan range hoods provide the high quality you expect and the value you demand.
• Installs as 7" round ducted only; built-in 7" adapter included.
• E Z1 installation kit included.
• 190 CFM, 6.0 sone (vertical discharge) performance.
• Dishwasher-safe aluminum grease filter.
• Accepts up to 75-watt light (bulb sold separately).
• BP87Q damper sold separately.
• ADA compliant, remote operation using a standard UL approved wall switch.
• Installs as 3-1/4" x 10" ducted only; built-in adapter/damper included.
• E Z1 installation kit included.
• 160 CFM, 6.5 sone (vertical or horizontal discharge) performance.
• Dishwasher-safe aluminum grease filter.
• Accepts up to 75-watt light (bulb sold separately).
• ADA compliant, remote operation using a standard UL approved wall switch.







Introducing our easy installation system to Broan’s economy range hood offering. Broan range hoods provide the high quality you expect and the value you demand.
• Features enclosed light and fan/filter assembly for easy clean-up.
• E Z1 installation kit included.
• Two-speed, rocker-type fan control.
• Powerful 190 CFM, 7.0 sone (3-1⁄4" x 10" vertical discharge) or 220 CFM, 8.0 sone (7" round discharge) performance.
• Accepts up to 75-watt light (bulb not included).
• Includes 3-1⁄4" x 10" damper/adapter and built-in 7" round adapter.
• 7" round damper optional.
• BP87Q dampers sold separately.
• ADA compliant, remote operation using a standard UL approved wall switch.
• Installs as non-ducted only with charcoal filter.
• E Z1 installation kit included.
• Accepts up to 75-watt light (bulb sold separately).
• ADA compliant, remote operation using a standard UL approved wall switch.










These four-way convertible range hoods will fit into most all applications. Enclosed light and fan/filter assemblies make for easy cleaning.
• Features enclosed light and fan/filter assembly for easy clean-up.
• Two-speed, rocker-type fan control.
• 260 MAX Blower CFM (7" round), 8.0 sones.
• Accepts up to 75-watt light (bulb not included).
• Includes 3-1⁄4" x 10" damper/adapter and built-in 7" round adapter.
• 7" round damper optional.
• BP87Q dampers sold separately.
• ADA compliant, remote operation using a standard UL approved wall switch.
43000 SPECIFICATIONS
43000 not available in 24 or 42" widths 43000/F40000

• Four-way convertible; installs ducted 3-1⁄4" x 10" (vertical and horizontal), 7" round (vertical) and non-ducted (non-ducted filter sold separately).
• 230 MAX Blower CFM (7" round), 6.5 sones.
• Accepts up to 75-watt light (bulb sold separately)
• Dishwasher-safe aluminum grease filter.
• Includes 3-1⁄4" x 10" damper/adapter and 7" round adapter.
• 7" round damper optional.
• BP87Q dampers sold separately.
• ADA compliant, remote operation using a standard UL approved wall switch.
OPTIONAL ACCESSORIES







Broan range hoods provide the high quality you expect and the value you demand.
• Installs as 7" round ducted only.
• 230 MAX Blower CFM (7” round), 6.0 sones.
• Dishwasher-safe aluminum grease filter.
• Accepts up to 75-watt light (bulb sold separately).
• Built-in 7" adapter included.
• BP87Q damper sold separately.
• ADA compliant, remote operation using a standard UL approved wall switch.
• Installs as 3-1/4" x 10" ducted only.
• 210 MAX Blower CFM, 6.5 sones.
• Dishwasher-safe aluminum grease filter.
• Accepts up to 75-watt light (bulb sold separately).
• Duct connector with built-in damper included.
• ADA compliant, remote operation using a standard UL approved wall switch.
• The 37000 Series utilizes the 40000 Series, but contains no fan, light or switch knock-outs.







Broan range hoods provide the high quality you expect and the value you demand.
• Installs as non-ducted only with charcoal filter.
• Accepts up to 75-watt light (bulb sold separately).
• ADA compliant, remote operation is possible using a standard UL approved wall switch. SPECIFICATIONS OPTIONAL ACCESSORIES





Help keep your kitchen looking like new.
• Provides easy clean-up of cooking splatter.


REVERSIBLE BISQUE /BLACK
SP240223
SP300223
SP360223
REVERSIBLE WHITE/ALMOND
SP240108
SP300108
SP360108
• Durable, attractive appliance-matching finishes: Reversible White/Almond, Reversible Bisque/Black.
• Aluminum or 24-gauge stainless steel.
• Available in 24", 30", 36" or 42" widths; all are 24" high.
• Installs easily with four screws (not included).

Genuine Broan replacement grease filters and odor-capturing non-ducted charcoal filters are the key to removing cooking effluents from your kitchen. The table below will help you find the filter model matched to your Broan range hood. Select filters are interchangeable on select hoods.


FITS RANGE HOOD SERIES
RMIP33
RMIP45
RM50000, RMP17004
E54000



NON-DUCTED CHARCOAL FILTER


REPLACEMENT GREASE FILTER DESCRIPTION
RBFIP33
RBFIP45
FILTEREB40
FILTERSQUARE
41000, F40000, 46000, BUEZ1 41F
40000, F40000, 42000, 46000, BUEZ0, BUEZ2
43000, BUEZ3
43000, BUEZ3
BCDF, BKDB, BKSH*
BCDJ*
BCSD, BCSEK*, ALT1, BCSD, BCSEK, TEN2*
ALT2, BKDF*, BKDEG*
BKSA, TEN1*
ALT3, BPDP, SPE1*
ALT4
*Filter type shown in parentheses.
BP58
HPF30 (Type Xc), HPF36 (Type Xd), HPF42 (Type Xe)
HPF30 (Type Xc), HPF36 (Type Xd), HPF42 (Type Xe)
HPF30 (Type Xc), HPF36 (Type Xd), HPF42 (Type Xe)
BP29
Qty 3
BP57 w/charcoal pad w/light lens
HPFAMM30 (C2), HPFAMM36 (D2), HPFAMM42 (E2)
HPFA3B30 (C4), HPFA3B36 (D4), HPFA3B42 (E4)
Qty 2 for 30", 36", 42"
Qty 2 for 30", 36", 42"
HPFA130 (C1), HPFA136 (D1), HPFA142 (E1) Qty 2 for 30", 36", 42"
HPF30 (Type Xc), HPF36 (Type Xd)HPFA3A30 (C3), HPFA3A36 (D3)Qty 2 for 30", 36"
HPF1 (Type Xa)
HPF24 (Type Xb), HPF30 (Type Xc), HPF36 (Type Xd), HPF42 (Type Xe)
HPF52 (Type Xh2)
HPFA (A0)
HPF424 (B5), HPFA430 (C5), HPFA436 (D5), HPFA442 (E5)
Qty 1 for 30"
Qty 2 for 30", 36", 42", 48"
HPFA52 (H2) Qty 2 for 30", 36"
Broan® Automatic Make-Up Air Dampers are the first to provide synchronized operation for kitchen, bath and whole-house ventilation products. Installation is simple and requires no special wiring. Intelligent design options ensure optimum performance in a variety of installations and applications. Highly effective and affordable, Broan Automatic Make-Up Air Dampers strike the perfect balance to keep you and your home breathing easy.
• Economical, ruggedly constructed galvanized motorized damper.
• Can be controlled by more than one Broan ventilation product.
• Damper opens automatically to replace the air being exhausted by ventilation fans or range hoods, and then closes tightly when ventilation fans are turned off.
• Prevents excess air from entering the home during heating or cooling operation, reducing energy consumption.
• Interlocked systems meet IRC code requirements for make-up air with range hoods.
• Fresh air inlets are required—see the table below.
Universal Design
• Works with any Broan range hood over 300 CFM.
• Provides interlocked make-up air.
• No direct wire connection required.
• Requires use of Broan fresh air inlets.
• Works with Broan range hood models: EI59, EW56, EW58, E64, E60.
• Requires direct wire to hood.
• Requires use of Broan fresh air inlets.

FRESH AIR INLETS (REQUIRED)
Damper Model Diameter Fresh Air Inlet Model
MD6TU/MD6T 6" 641FA
MD8TU/MD8T 8" 643FA
MD10TU/MD10T 10" 610FA
Online Range Hood Make-Up Air Specifying Tool guides the design of the right make-up air damper system for any home. Try it at broan-nutone.com/make-up-air.
MD6TU/8TU/10TU installation
Switched Voltage Sensor Low Voltage Transformer
Works with all Broan range hoods over 300 CFM
Fresh Air Inlet
Make-Up Air Damper (normally closed) optimally installed in air return duct of forced-air system
MD6T/8T/10T installation
Switched Voltage Low Voltage Transformer
For use with Broan range hood models: EI59, EW56, EW58, E64 and E60
Fresh Air Inlet
Make-Up Air Damper (normally closed) optimally installed in air return duct of forced-air system
Stock No. Description
35
AC Cord Kit
Wall Hanging Kit—for mounting hoods to wall when not hung from overhead cabinets. Designed for use with 46000, 43000, 42000, 41000, F40000, 40000 series.
HCK44 HCK44 (10-pack) Electric cord connections kit.
SHCK44 (Single-pack) Electric cord connections kit.
634 Paintable roof cap with backdraft damper and bird screen; 3-1/4" x 10" or up to 8" round duct. Black finish.
644 Aluminum roof cap with backdraft damper and bird screen; 3-1/4" x 10" or up to 8" round duct. Natural finish.
437 High-capacity roof cap–up to 1200 CFM exhaust with spring-loaded damper and bird screen.
611 Aluminum roof cap for flat roofs, 8" round duct.
612 Aluminum roof cap for flat roofs, 10" round duct.
639 Paintable wall cap with backdraft damper and bird screen; 3-1/4" x 10" duct. Black finish.
WC638 Paintable wall cap with backdraft damper and bird screen; 3-1/4" x 14" duct. Black finish.
649 Aluminum wall cap with backdraft damper and bird screen; 3-1/4" x 10" duct. Natural finish.
641 Aluminum wall cap for 6" round duct, with backdraft damper and bird screen.
641FA Aluminum fresh air inlet wall cap for 6" round duct.
647 Aluminum wall cap for 7" round duct, with damper and bird screen.
610FA 10" Aluminum Fresh air inlet.
643 Aluminum wall cap; 8" round duct with damper.
643FA Aluminum fresh air inlet wall cap for 8" round duct.
441 Wall cap with gravity damper; 13-1/8" sq. fits 10" round duct.
BP87Q 7" round discharge damper with sound dampening.
97 7" spring-loaded, In-Line damper.
438 8" round section with In-Line damper.
421 10" vertical discharge In-Line damper.
Stock No. Description
411 3-1/4" x 10" to 6" round transition.
412H 3-1/4" x 10" to 7" round transition.
T460 3-1/4" x 14" to 7" round transition.
413 3-1/4" x 10" to 8" round transition.
459 3-1/4" x 14" to 8" round transition.
T461 3-1/4" x 14" to 3-1/4" x 10" transition.
414 8" to 10" expander.
889 3-1/4" x 10" duct; 2' section.
430 Short eave elbow for 31⁄4" x 10" duct with backdraft damper and grill.
431 Long eave elbow for 31⁄4" x 10" duct with backdraft damper and grill.
419 6" adjustable elbow (individual).
415 7" adjustable elbow (carton of four).
432 8" adjustable elbow (individual).
418 10" adjustable elbow (individual).
MD6S 6" Slave Make-Up Air Damper.
MD8S 8" Slave Make-Up Air Damper.
MD10S 10" Slave Make-Up Air Damper.
MD6T 6" Broan Make-Up Air Damper.
MD8T 8" Broan Make-Up Air Damper.
MD10T 10" Broan Make-Up Air Damper.
MD6TU 6" Universal Make-Up Air Damper.
MD8TU 8" Universal Make-Up Air Damper.
MD10TU 10" Universal Make-Up Air Damper.


Our Exterior blowers offer you powerful ventilation performance at its very quietest, and something you won’t find anywhere else—Broan quality.
All Exterior blowers can be installed on the roof or to an outside wall for the ultimate in quiet, high performance kitchen ventilation. Quietest sound level is achieved when the blower is mounted at least 10' from the hood location and incorporates a 90 degree elbow in the duct run.




HLB3 (320 MAX Blower CFM)
HLB6 (670 MAX Blower CFM)
HLB9 (890 MAX Blower CFM)
HLB11 (1540 MAX Blower CFM)
P5 (530 MAX Blower CFM vertical)
P8 (930 MAX Blower CFM vertical)
This quiet performance solution is a perfect alternative to Internal or Exterior blowers. Works with all Broan range hoods designed for use with External blowers.
• Powerful and quiet, In-Line blowers are available in a rangeof CFM ratings to match your cooking preferences and ventilation requirements.
• Installs remotely in the interior of the home—not restricted by local exterior home codes or service concerns for roof-mounted exterior applications.
• Reduce kitchen noise by locating your range hood blower outdoors.
• For use with our professional style Broan Elite E64000, E60000, EX Series chimney hoods, downdrafts, RMPE Power Pack and RMIP Inserts.
• Ideal for custom hoods—use the 72W (6 amp variable speed) wall control for remote control of External blowers.
• The 332H is recommended for the Eclipse downdraft.
• Residential design fits unobtrusively on home exterior.
• Durable, weather-resistant, all-aluminum construction that mounts on the roof or outside wall.
• Safety screen keeps small animals and debris away from blower and motor.
Broan Elite Internal blowers provide high ventilation and durable construction to meet the needs of professional-style cooking appliances for the home.
• Eight-position mounting brackets, or suspends with special suspension chains (hanger kit included).
• Designed to work independently from Internal or Exterior blowers, this is not a boost blower—the HLB series needs no other blowers in the system.
• Specially designed resilient motor mounts and housing isolation mounts prevent vibration noise.
• Flexible duct design allows straight-through or right-angle connections with built-in damper.
• Includes 10" round ductwork transition(s).
• The P5 (530 MAX Blower CFM) and P8 (930 MAX Blower CFM) blowers are designed for use with RMIP Inserts.
• All blowers are designed for quiet operation using the finest motors and balance wheels.
• Rough-In Kits are included to make the installation clean and simple.
* Broan internal and external blowers are designed and UL Listed for use with Broan products only. Use with other manufacturers’ products cannot be recommended. Broan range hoods can be used to comply with California Title 24.
1. Distance from cooking surface:
For optimal performance, the distance from the cooking surface to the bottom of the range hood should be between 24" to 30", unless otherwise noted. DO NOT install a Broan Elite range hood less than 24" above cooking surface.
To maintain hood performance at heights greater than the recommended range, use the following guidelines:
• For every 3" increase in installation height, add 100 CFM to the minimum exhaust requirement and/or a minimum of 3" to the hood/liner width (may require going to the next hood width).
Installation Example:
2. Range hood width:
The hood should never be less than the width of the cooktop.
3. Required blower CFM based on cooktop BTU output.
For gas cooktops under 60,000 BTUs, or electric choose a blower with a minimum of 100 CFM per lineal foot of your cooktop width. For example, a 36" wide cooktop requires a blower with a minimum of 300 CFM.
• High heat cooking or aromatic foods may require additional CFM. Always check with the range manufacturer. NOTE: Increasing capture area by 3" on each side is also a recommended way to address this issue.
A consumer purchases a cooktop with these specifications:
• Four burner, 36" cooktop
• Burner output is 60,000 BTU
• The cooktop features a grill
• Installation requirements call for the range hood to be 33" over the range (3" above recommended maximum height)
Blower CFM Option 1:
• A s a means to estimate the approximate CFM requirement for cooktops OVER 60,000 BTUs, choose a blower with 1 CFM per 100 BTU of cooktop output. To quickly calculate this number, add the BTU output from all burners and drop the last two zeros. For example, if the total BTU output of the cooktop burners is 65,000 BTUs, choose a blower with at least 650 CFM.
4. Additional CFM needs for a Grill or Griddle:
If your cooktop has a grill or griddle, ADD 200 CFM to your estimated CFM needs as calculated in step 3. For example, if your cooktop BTU output requires a 650 CFM blower, add 200 CFM for a total of 850 CFM.
(Using the guidelines above) The blower must equal a minimum of 600 CFM (60,000 BTU) + 200 CFM (for Grill requirement) + 100 CFM (for 3" of installation height) = 900 CFM
Blower CFM Option 2:
(Using the guidelines above) Select a range hood that is a minimum of 3" WIDER than the cooktop, a minimum 600 CFM (60,000 BTU) + 200 CFM (for Grill requirement) = 800 CFM
†† Model 332KR Rough-In Kit required for installation with hood series RM60000, 64000 and RMIP (Model 421 10" In-Line damper recommended for Exterior blowers).
* Straight CFM/Right angled CFM (rated with transitions provided).
† Transitions provided with unit.
^ Not recommended for use with grill applications.
* Mounting Height is measured from the top of the cooktop to the bottom of the hood filter.
* * V isible height of Chimney when in the raised position.
* ** Minimum Height is 24" when using optional RMP series backsplash.
† SS=430 Stainless Steel, BL=Black on Black, WW=White with color-matched controls, WH=White with contrasting controls.
†† (Normal Setting).
Broan range hoods are tested and certified by the Home Ventilating Institute. This is your assurance that each Broan unit has been tested and found to consistently deliver the air and sound performance specified.
* Mounting Height is measured from the top of the cooktop to the bottom of the hood filter.
† SS=430 Stainless Steel, BL=Black on Black, BLS=Black Stainless Steel, SL=Slate, BT=Bisque w/Black controls, BC=Bisque on Bisque, WW=White with color-matched controls, WH=White with contrasting controls.
†† (Normal Setting).
†††
RMIP Series requires 332KR Rough-In Kit when used with Exterior or In-Line blowers.
Broan range hoods are tested and certified by the Home Ventilating Institute. This is your assurance that each Broan unit has been tested and found to consistently deliver the air and sound performance specified.
† SS=430 Stainless Steel, BL=Black on Black, BLS=Black Stainless Steel, SL=Slate, BT=Bisque w/Black controls, BC=Bisque on Bisque, WW=White with color-matched controls, WH=White with contrasting controls.
†† (Normal Setting).
††† External blower for E60000, E64000, 61000EX, 63000EX, RMPE, RMIP, RMDDEX and E66000 Series.
Broan range hoods are tested and certified by the Home Ventilating Institute. This is your assurance that each Broan unit has been tested and found to consistently deliver the air and sound performance specified.
Overture™ is a simple solution that automatically manages indoor air quality. Comprised of a wall switch, a room sensor and a smart plug, Overture™ monitors humidity, TVOCs, CO2 and temperature. When any of these factors exceed normal levels, Overture™ devices automatically start your compatible range hood and ventilation fans to exhaust bad air. And with the Smart Plug controlling your air supply unit, fresh air is introduced concurrently.




The Overture™ app enables you to monitor air quality from anywhere, anytime. Monitor any room—even in different homes.




Fresh, clean air is essential to life.
In fact, we take around 25,000 breaths each day with most of those breaths taken at home. They are taken around the kitchen table, during bath time, and while we are asleep. Going about daily life at home creates things like humidity, dust, chemicals, smoke, and carbon dioxide, which reduces the quality of the air in the home. The buildup of these pollutants inside homes can reach levels that are up to five times more polluted than the air outside. At Broan-NuTone, we believe every one of our breaths taken at home should be a healthy one, so we have created the first, fully integrated and cloud-connected whole home indoor air quality monitoring and ventilation system, that we are calling Overture, to provide homes with clean, healthy air without the need for remembering to turn on and off your home’s ventilation systems. Overture is here to help you make sure your home is safer, cleaner, and more comfortable.




Scan this code to learn more about Overture™ and the complete range of compatible ventilation solutions.

 Smart Room Sensor Model BIAQRS1
Smart Wall Control Model BIAQWC1
Smart Plug Model BIAQSP1
Smart Room Sensor Model BIAQRS1
Smart Wall Control Model BIAQWC1
Smart Plug Model BIAQSP1
Broan-NuTone® is America’s leading brand of residential ventilation products including range hoods, ventilation fans, fresh air systems, electric and solar-powered attic ventilators.


For today’s tightly constructed, energy efficient homes, Broan Heat Recovery Ventilators (HRVs) continuously supply fresh air to improve indoor air quality in every season. These fresh air systems exchange stale indoor air and pollutants with fresh, filtered outside air. Our core technology tempers incoming air to help maintain optimal indoor temperature levels.Theresult—freshairinyourhome,allyearlong.



For today’s tightly constructed, energy efficient homes, Broan Heat Recovery Ventilators (HRVs) continuously supply fresh air to improve indoor air quality in every season. These fresh air systems exchange stale indoor air and pollutants with fresh, filtered outside air. Our core technology tempers incoming air to help maintain optimal indoor temperature levels. The result—fresh air in your home, all year long.






low speed.
3 This product earned the ENERGY STAR® rating by meeting strict energy efficiency guidelines set by Natural Resources Canada and the U.S. EPA.
It meets ENERGY STAR® requirements only when used in Canada.
Heating Season Minneapolis, Minnesota Cooling Season Phoenix, Arizona
Outside air to house –13°F
7°F Stale air to outside

Stale air from building 75°F
Pretreated air to house 61°F2


Outside air to house 110°F Stale air from building 75°F
105°F Stale air to outside Pretreated air to house 83°F




Residential Main Wall Controls Broan® offers simple to more advanced wall controls to customize your fresh air system.





VT4W
Select the wall control best suited to your needs
Auxiliary Wall Controls can provide additional control to homeowners.


VB60W
Accessories*
WHISPER REGISTERS
Model V01269
• 4" intake and exhaust
Model V02863
• 5" intake and exhaust
Model V01271
• 6" intake and exhaust
Model V03585
• 8" intake and exhaust
EXTERIOR VENTS
Model VTYIK1
• Tandem transition kit for units at 110 CFM and under
Model V1607100
• IN2000 hood kit (set 2)
Model V12570
• Anti-gust intake 6"
Model 634M
• Roof cap up to 6"
GRILLES AND PLASTIC REGISTERS
Model V04790
• Duct connector baffle 8" x 12"
Model V04400
• Duct connector 8" x 12"
AIRFLOW BALANCING KITS
Model V18222
• Balancing kit 0.5" and 1" H20
Model V11001
• Air flow collar 6"d
Model V11246
• Air flow collar 8"d
Model V11247
• Air flow collar 7"d



At Carro USA Inc., we live and breathe with one focus: create smart technology to improve the quality and comfort of the home. For nearly 2 decades we’ve been dedicated to building exceptionally engineered and magnificently designed smart ceiling fans, smart switches, lighting products, and other home goods all devoted to improving home life. Our motto is that a “Smart Life Stays in Motion”, life is busy and with smart technologywecanaddconveniencesthatgrantusmoretime tokeeplifemoving.














































































































CarroUSA Inc. is a well-known global supplier that produce ceiling fans, smartswitches, lighting and other home goods. We supply to hundreds of local,online, and international distributors.
For nearly 2 decades we’ve been dedicating in building exceptionally engineered and magnificently designed smart ceiling fans, lighting products, smart switches and other homegoodsalldedicatedtoimprovinghomelife.




















































